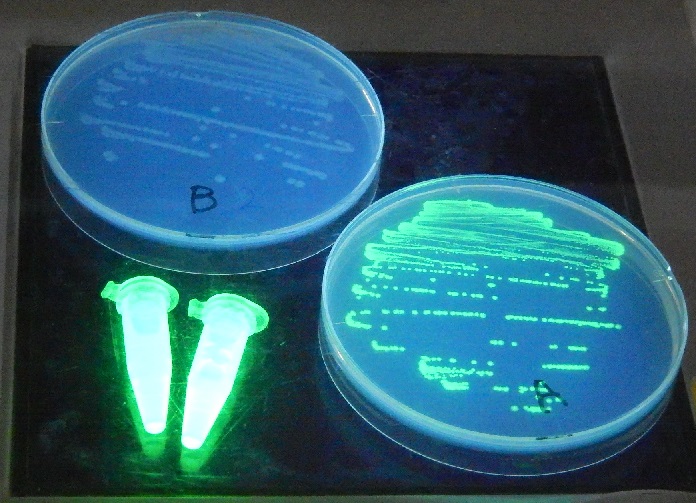

ここには,会員個々の活動やそれぞれが所属する関連団体などの活動を報告します。
(会発足は1997年2月ですが,ここには,ホームページ作成以降の活動を報告します。)
- R0 番外編 到津の森公園訪問
R1 がんばるブラジルチドメグサに負けなかった筑後市アサザ個体群の現状
R1-1 ブラジルチドメグサのねばり
R1-2 復活を続ける?筑後市のアサザ個体群
2021年
2022年
2023年
2024年
R2 八女の自然に親しむ会2019年~
2019年
2020年
2021年
2022年
(2023年以降は,R2-2 八女の自然に親しむ解2023年~
2023年
R3 日生教2019年岡山大会から
R4 日生教2021年長野大会から
R0 番外編 到津の森公園訪問(2018年11月25日)
日本生物教育学会の九州支部の研修会が到津の森公園で行われました。この研修会はフリーエントリーとまではいきませんが,生き物に関する教育活動に関係している人は会員外でも一定の人数枠内であれば参加できます。ちなみに,会員外の参加費は5百円プラス入園料となります。
園の女性獣医さんに講話の後に園内を案内してもらいました。彼女たちの自慢は動物とも信頼関係です。「○○とは友達ですから呼んだら来ますよ。」とのこと。本当に来るんですね。私は呼ばれて近づいてきたチンパンジーがあまりに優しい目をしているのに驚きました(写真なし)。呼ばれて近づいてきたレッサーパンダもしばらくカメラサービスをしてくれました。これなら園のホームページにアクセスすると名前を調べることもできます。レッサーパンダは一応猛獣とのことですが,麻酔なしで採血ができるそうです。
私は,動物園はどうも苦手でした。というのも,檻に入った動物たちがかわいそうでならなかったからです。しかし,到津の森公園では少し違っていました。圧迫感を少なくするような工夫が随所にみられます。もし,動物園を教育活動に取り入れたいと思われる方がおられましたら,到津の森公園の獣医さんに連絡を取ってみてはいかがですか。
(H,S)
R1 がんばるブラジルチドメグサ(2019年~) に負けなかった筑後市アサザ個体群の現状
2021年からテーマを「がんばるブラジルチドメグサ」から「がんばるブラジルチドメグサに負けなかった筑後市アサザ個体群の現状」に変更しました。
(H,S)
R1-1 ブラジルチドメグサのねばり
-
ブラジルチドメグサ1月
先月除去した場所に,いつの間にかまた侵入しています。
(筑後市,2019年1月14日) -
アサザ1月
冬のアサザは浮葉がなくなり,春をまつ赤い小さな沈水葉のみになります。茎は大部分かれ,節の部分に根を形成しているのがよく見られます。場合によってはそれぞれが千切れて流れていきます。
(筑後市,2019年2月10日) -
ブラジルチドメグサ2月
またまた出現した個体
(筑後市,2019年2月10日 -
アサザ2月
新天地1のアサザの様子。
水位が下がり,葉が地上に出ています。
(筑後市,2019年2月10日) -
ブラジルチドメグサ3月
草影に流れ着くと発見されるのが遅れる場合があるようです。
(筑後市,2019年3月9日) -
アサザ3月
水温が上昇してくると,浮葉の数が増えてきます。
(筑後市,2019年3月9日) -
ブラジルチドメグサ4月
残念ながらまた出現ですね。
(筑後市,2019年4月6日) -
アサザ4月
浮葉を展開し始めました。初めてアサザの被度がブラジルチドメグサを上まわりました。
(筑後市,2019年4月6日) -
ブラジルチドメグサ5月
アサザの上に覆い被さっています。
(筑後市,2019年5月6日) -
アサザ5月
一部で開花が始まりました。
(筑後市,2019年5月6日) -
ブラジルチドメグサ6月
除去できなかった栄養体が復活した感があります。根はしっかりと張っていました。
(筑後市,2019年6月3日) -
アサザ6月
地上部に除草剤が撒かれた水路西側が今回はもっともよく葉を展開していました。多くの果実を実らせた栄養体があったのもこのあたりでした。
(筑後市,2019年6月3日) -
ノハナショウブ
前年位から水際で繁殖しています。少し勢力を増しているようにも思われます。
(筑後市,2019年6月3日) -
矢部川本流のブラジルチドメグサ
千間土居公園の対岸のブラジルチドメグサの繁殖の様子。写真水際の部分。調査ではなく,通過しただけでも大小の塊が複数確認できました。(八女市,2019年6月9日)
-
ブラジルチドメグサ7月
気温の上昇とともに,ブラジルチドメグサの栄養体の成長も速くなるようです。
(筑後市,2019年7月6日) -
アサザの隙間に漂着したブラジルチドメグサ
このような隙間に漂着すると流れの影響を受けにくくなります。
(筑後市,2019年7月6日) -
アサザに紛れ込むブラジルチドメグサ
一見小さな栄養体に見えますが,駆除してみると案外大きいのでびっくりしました。
(筑後市,2019年8月3日) -
ブラジルチドメグサ葉からの発根?
厳密に葉1枚から発根しているかは微妙ですが,極めて1枚の葉に近い状態からの発根です。
(筑後市,2019年8月3日) -
イトトンボの仲間の産卵
イトトンボの仲間が産卵していました。テレビでは見たことがあったのですが,なんと,ペアで潜水していきました。
(筑後市,2019年8月3日) -
イトトンボの仲間が産卵(水中)
水中の護岸ブロックにも産卵していました。
(筑後市,2019年8月3日) -
水路の様子9月
アサザは前年より繁殖の状態はよいように思われます。ブラジルチドメグサは一見では確認できませんが・・・
(筑後市,2019年9月9日) -
ブラジルチドメグサ9月
アサザの中に紛れ込んでいます。
(筑後市,2019年9月9日) -
シオヤトンボ♂
シオカラトンボにそっくりですが,やや小ぶりです。
(筑後市,2019年9月9日) -
タマスダレ
今年,初出現です。ヒトもしくは水流が種子を運んだのでしょうね。
(筑後市,2019年9月9日) -
ブラジルチドメグサ10月
今回もやはり漂着?していました。
(筑後市,2019年10月5日) -
アサザ10月
水温が高めに推移していることもあり,アサザの成長は前年よりよいようです。この中にブラジルチドメグサが紛れ込んでいるようには見えませんが・・・。
(筑後市,2019年10月5日) -
アサザ新天地3候補
アサザの種子もしくは栄養体から繁殖に成功した集団がある場所で,移植地と離れたものを新天地と呼んでいます。新天地の条件としては,繁殖が2年以上確認できること。
(筑後市,2019年10月5日) -
カロライナツユクサ?
今この外来のツユクサが筑後市近隣では大繁殖に成功しています。何でも,アリが種子を運ぶとかで?
(筑後市,2019年10月5日) -
ブラジルチドメグサ11月
この時期のブラジルチドメグサは何故か成長速度が速い気がします。
(筑後市,2019年11月4日) -
アサザ11月
今年は前年よりも生育の状態がよいようです。これを復活の兆しと捉えてもいいですかね。奥にはブラジルチドメグサが遠景でも確認できます。
(筑後市,2019年11月4日) -
マルバアメリカアサガオ
外来種です。いつのまにか侵入していました。
(筑後市,2019年11月4日) -
筑後広域公園公園のブラジルチドメグサ
細い水路をほぼ埋めつくす状況です。これを駆除するのは大変そうですね。
(筑後市,2019年11月10日) -
ブラジルチドメグサ12月-1
またもや多くのブラジルチドメグサが漂着していました。
(筑後市,2019年12月8日) -
ブラジルチドメグサ12月-2
セリの上に打ち上げられたブラジルチドメグサ。地上部分は干からびていて繁殖可能かどうかは不明ですが,水の上にある部分は元気です。
(筑後市,2019年12月8日) -
アサザ12月-1
移植された場所に生き残っているアサザは,浮葉が殆どなくなっています。
(筑後市,2019年12月8日) -
アサザ12月-2
周辺に逃げ出したアサザは,まだ浮葉を少し残していますが,根が地面から向けだして浮上しているものがいくつか見られました。
(筑後市,2019年12月8日) -
アサザ観察地
駆除しても駆除してもこのような断片が流れ着きます。
(筑後市,2020年3月8日) -
隣の水路
隣の水路で繁殖ののろしをあげたブラジルチドメグサ。水路が広いので一面を覆うのには時間がかかりそうです。この水路も時々ブラジルチドメグサの駆除を行っているようです。
(筑後市,2020年3月8日) -
地上部ののアサザ
水辺に完全に葉が地上部にあるアサザが複数観察されました。
(筑後市,2020年6月6日) -
アサザ2020年10月
最初に移植された部分の被度が少しずつ増加してきているようです。
(筑後市,2020年10月3日)
アサザの自生地とされる筑後市にある県の水路でのブラジルチドメグサについて報告します。特定外来生物の指定を受けているブラジルチドメグサの繁殖の実態を知っていただくためです。ブラジルチドメグサの繁殖の程度は,水路の大きさにも関係すると考えられますが,とりあえず,以下のように段階化しています。単独の栄養体もしくは一塊の栄養体の被覆面積の程度段階から,調査水路全体の被覆面積合計の程度段階の順に(1,2)のように記載することにしていきます。被覆面積は目分量ですので,かなり大雑把な比較になります。
[ブラジルチドメグサの繁殖の程度段階化(私案)]
0 ブラジルチドメグサの存在を確認できない
1 ブラジルチドメグサの被覆面積が1㎡未満
2 ブラジルチドメグサの被覆面積が1㎡~2㎡未満
3 ブラジルチドメグサの被覆面積が2㎡~4㎡未満
4 ブラジルチドメグサの被覆面積が4㎡~8㎡未満
5 ブラジルチドメグサの被覆面積が8㎡以上
(2019年1月14日)天気 晴れ 水温12.1℃
ブラジルチドメグサの繁殖の程度 (1,1)
(2019年2月10日)天気 晴れ 水温12.7℃
ブラジルチドメグサの繁殖の程度 (1,1)
(2019年3月9日)天気 曇り 水温15.4℃
ブラジルチドメグサの繁殖の程度 (1,1)
ブラジルチドメグサの繁殖の程度は,1~3月で数値的には変化していないですが,だんだん増加の傾向にあります。ちなみに昨年の値は,1・2月はゼロでしたので要警戒です。
(2019年4月6日)天気 晴れ 水温18.4℃
ブラジルチドメグサの繁殖の程度 (1,1)
ブラジルチドメグサの繁殖の程度は,数値的には変化していないですが,始めて被度が減少しました。
(2019年5月6日)天気 曇り 水温22.4℃
ブラジルチドメグサの繁殖の程度 (1,2)
いよいよブラジルチドメグサのシーズンが始まった感じです。今シーズン初めてアサザの上に覆い被さっているブラジルチドメグサが見られました。北側の水路から取水しているようで,取水路の途中にもブラジルチドメグサが浮かんでいました。
(2019年6月3日)天気 曇り・晴れ 水温25.2℃
ブラジルチドメグサの繁殖の程度 (1,1)
予想に反してブラジルチドメグサの栄養体は2個体のみでした。これは田植え前であることに加え,少雨傾向が続いているためだと思われます。また,アサザも昨年同様やや不調ですね。しかし,地上部に除草剤が撒かれ雑草が減少している西側は少し勢力を取り戻しつつあるかもしれません。アサザの周りを部分的に草刈りすることが有効に働く可能性を感じました。
(2019年6月9日)八女市立花町千間土居公園横の矢部川
ブラジルチドメグサの繁殖の程度 (5,5)
川の大きさが全く異なる場所で,ブラジルチドメグサの繁殖の程度を同じ基準を用いて評価するのは問題ありですが参考までに示しました。矢部川の本流に写真で示した大きな集団が複数繁殖しているのは問題ありですので,関係機関に連絡しました。
(2019年7月6日)天気 晴れ 水温25.2℃
ブラジルチドメグサの繁殖の程度 (1,3)
ブラジルチドメグサの栄養体は10個体前後でしたが,駆除した栄養体の中には被覆面積が1㎡に迫るものもありました。今回気づいたことは,アサザや水辺周辺の植物がブラジルチドメグサの漂着に一役かっているということです。ブラジルチドメグサは,まず,アサザや水辺の植物に漂着し,そこで栄養成長を行い,やがて水辺の土に根をおろし更なる成長へつなげるといった感じです。一度根をおろすとなかなか1回では駆除できるとは限りません。どうしても,栄養体の一部が残るからです。再び茎を伸ばし繁殖を再開します。これが,各地でブラジルチドメグサに手を焼いている要因の1つです。なお,アサザは前回と同様ですが,水は少し濁っているのですが中央部分の水中葉がまだ枯れずに頑張っているようです。なお,アサザは前回と同様ですが,水は少し濁っているのですが中央部分の水中葉がまだ枯れずに頑張っているようです。なお,ここで使用する水中葉とは,葉が水面に展開する前のものをいいます。アサザの場合,浮葉と水中葉とは大きな形態的差異はありませんが,水中葉の方がやや赤みを帯びることが多いようです。アサザの状態は雨が少なかったせいもあり昨年より少しましな状況です。
(2019年8月3日)天気 晴れ 水温28.7℃
ブラジルチドメグサの繁殖の程度 (1,2)
ブラジルチドメグサの栄養体を4カ所で駆除しましかが,3カ所はアサザの隙間に紛れ込んでいました。また,ほぼ1枚の葉から発根しているものがありました。
(2019年9月9日)天気 晴れ 水温27.6℃
ブラジルチドメグサの繁殖の程度 (1,1)
遠くからの目視では確認できませんでしたが,ブラジルチドメグサの栄養体を2カ所で駆除しました。2カ所は共にアサザの隙間に紛れ込んでいました。周辺の水路でも,遠くからの目視ではブラジルチドメグサが確認できないようですから,駆除活動が行われた可能性があります。大雨の影響はわかりませんが,アサザに関しては昨年よりやや繁殖の状態はよいようです。水温は9月としては,この5年間で最高の値になっています。残暑が非常に酷しいということでしょう。
(2019年10月5日)天気 晴れ 水温24.3℃
ブラジルチドメグサの繁殖の程度 (1,1)
前月と同様に遠くからの目視では確認できませんでしたが,ブラジルチドメグサの栄養体を2カ所で駆除しました。2カ所は共にアサザの隙間に紛れ込んでいました。そのうち1カ所は,駆除をくぐり抜けた栄養体の一部が再び繁殖を始めたようで,複雑に周りの植物に入り込んでいました。周辺の水路でも,遠くからの目視ではブラジルチドメグサが確認できないようです。アサザに関しては昨年よりやや繁殖の状態はよいようです。これは,水深が浅くなったことと,水温が高いことが影響していると思われます。水温は先月に引き続き10月としては,この5年間で最高の値になっています。
(2019年11月4日)天気 晴れ 水温18.6℃
ブラジルチドメグサの繁殖の程度 (2,3)
前月と同様の結果を期待していましたが,今年最大規模の駆除となりました。前年も同様な傾向がありましたが,この時期に栄養体の成長を促進する要素がありそうですね。なお,種子からの発芽も否定できません。ブラジルチドメグサの駆除が多くの場所で問題になっていますが,晩秋の駆除が有効であるような気がします。なお,アサザの方もボチボチですね。
(2019年11月10日)天気 晴れ 筑後市津島筑後広域公園
ブラジルチドメグサの繁殖の程度 (5,5)
矢部川本流の時と同様に川の大きさが全く異なる場所を同じ基準で評価するのは問題ありですが,公園内の細い水路にびっしりと繁殖している様子は脅威ですね。これを駆除するには,公園管理者等の不断の努力が必要でしょう。原因の1つは,今年の大雨と台風かもしれません。この場所は水没していたとのことです。
(2019年12月8日)天気 晴れ 水温12.2℃
ブラジルチドメグサの繁殖の程度 (1,2)
急激に冬が訪れた感がありますが,ブラジルチドメグサは相変わらず元気でした。駆除した栄養体の断片をすべて確認しましたが,11月とは異なり地面に深く根づいているものはありませんでした。前月の駆除がほぼ成功していたと考えられます。しかし,漂着した栄養体の断片の中には側面に根づく直前のものも2~3個体見られました。不断の駆除努力を怠れば大繁殖が可能になりそうな感じです。なお,アサザは開花を終了しており,中央の移植部分は浮葉が消えて水中葉のみになりつつありました。側面では浮葉がかなり残っており,一部は根の部分が浮上して千切れて旅立つ準備が始まっているようです。
(2019年総括)
筑後市のアサザ生育地(県の水路)という狭い領域でのブラジルチドメグサ駆除活動は一定の効果があると思われますが,未だに撲滅までには至っていません。それは,不定期的なブラジルチドメグサの移入が続いているからです。この問題の解決には水系全体としての取り組みが必要でしょう。
ページ先頭へ
(2020年1月5日)天気 晴れ 水温11.0℃
ブラジルチドメグサの繁殖の程度 (1,1)
ブラジルチドメグサの小さな栄養体の断片を3個駆除しましたが,いずれも根は地下部にとどいておらず新たに漂着したものと思われます。供給ルートの解明も必要かもしれません。
アサザはほぼ活動を休止しており,中央の移植部分にはほとんど葉が見られなくなっています。側面では浮葉は一部残ってはいましたが,なくなるのは時間の問題のようです。
さて,今年からはブラジルチドメグサやアサザの状況に例年と比べて大きな変化がない場合には,写真の掲載を中止して周辺の生き物を紹介することにします。
(2020年2月2日)天気 晴れ 水温14.5℃
ブラジルチドメグサの繁殖の程度 (1,1)
ブラジルチドメグサは漂着したと思われる栄養体が栄養成長を進めていました。水温は2月の測定データの中で最高,未だ初雪も観測されておらずこのまま春に向かいそうな雰囲気の中,心なしかブラジルチドメグサの成長も速い気がします。アサザはほぼ活動を休止しており,すべての場所で水中葉のみになっているか僅かに赤い小葉を水上に覗かせている程度かです。
(2020年3月8日)天気 晴れ 水温14.7℃
ブラジルチドメグサの繁殖の程度 (1,1)
ブラジルチドメグサは漂着したと思われる小さな栄養体が2つありました。となりの国担当の水路では,ブラジルチドメグサの春の繁殖が始まっていました。矢部川本流の時と同様に川の大きさがやや広い水路を同じ基準で評価するのは問題ありですが,ブラジルチドメグサの繁殖の程度は(5,5)です。繁殖速度が急激にあがり始めるこの時期に最初の駆除作戦を展開するのが得策と考えていますので,下に紹介する筑後川河川事務所に連絡することにします。となりの水路も昨年秋には遠くからの目視ではブラジルチドメグサが確認できない状態でしたので,やはりその繁殖力は驚異です。今年はブラジルチドメグサの状況の写真は載せない予定でしたが,3月は参考のために掲載することにします。アサザも活動を徐々に開始しており葉が水面に届いているものもありました。
(筑後川河川事務所のホームページより)
筑後川河川事務所では、筑後川・矢部川水系の水質汚濁対策の観点より、ブラジルチドメグササの繁茂に関する情報を収集・整理し、関係自治体と協力して、拡散防止に努めていきます。
ブラジルチドメグサを発見されましたら、下記まで連絡をお願いします。
筑後川河川事務所 河川環境課 TEL0942-33-9193(直通)
(追記)
上記の連絡先に電話しましたが,「筑後川・矢部川水系で対応できるのは,本流のみで,小さな水路は市または県の担当になる。」とのことでした。この場所も時々ブラジルチドメグサの駆除をしていますので,順番まちと推察いたします。
(2020年4月4日)天気 晴れ 水温14.7℃
ブラジルチドメグサの繁殖の程度 (1,1)
ブラジルチドメグサは漂着したと思われる小さな栄養体が4つありました。となりの国担当の水路(通常は下)で大繁殖していたブラジルチドメグサは一部駆除され,除草剤を使用されたような形跡もありました。田植えに向けて水位が調整されているらしく,広範囲に水面の高さがほぼ同じになっていました。水の流れがなくなると風などでブラジルチドメグサが流れ込む可能性が増します。
アサザは暖冬のためか昨年より成長が速いようです。
(2020年5月5日)天気 晴れ 水温23.7℃
ブラジルチドメグサの繁殖の程度 (1,1)
ブラジルチドメグサは漂着したと思われる栄養体断片が10個程度ありました。二日前の雨のためではないかと思われます。となりの国担当の水路(通常は下)で大繁殖していたブラジルチドメグサは駆除され一部の生き残りがまた元気に増えだしているようです。
アサザは肝心の4月がやや低温であったためか成長が少し遅れているようです。
(2020年6月6日)天気 曇り 水温24.8℃
ブラジルチドメグサの繁殖の程度 (0,0)
久しぶりに観察水路内でブラジルチドメグサの漂着が観察されませんでした。となりの国担当の水路(通常は下)でブラジルチドメグサはまだ元気に増えだしているようです。アサザの生育は相変わらずよくないようです。地上部のみ開花が観察されました。
(2020年7月4日)天気 晴れ 水温24.6℃
ブラジルチドメグサの繁殖の程度 (0,0)
2ヶ月連続でブラジルチドメグサの漂着が観察されませんでした。となりの国担当の水路(通常は下)でもブラジルチドメグサが駆除されていました。アサザは浮葉を少しずつ展開しており復活の兆しがあります。
(2020年8月2日)天気 晴れ 水温26.0℃
ブラジルチドメグサの繁殖の程度 (0,0)
3ヶ月連続でブラジルチドメグサの漂着が観察されませんでした。となりの国担当の水路(通常は下)でもブラジルチドメグサは遠くからの目視では確認できません。アサザは浮葉を前年より展開しており復活の兆しが続いています。
(2020年9月13日)天気 晴れ 水温24.9℃
ブラジルチドメグサの繁殖の程度 (0,0)
4ヶ月連続でブラジルチドメグサの漂着が観察されませんでした。となりの国担当の水路(通常は下)でもブラジルチドメグサは遠くからの目視では確認できません。ブラジルチドメグサの駆除活動が少し盛んになっているかもしれません。
アサザは前月に引き続き浮葉を前年より展開しており復活の兆しが続いています。
(2020年10月3日)天気 晴れ 水温23.5℃
ブラジルチドメグサの繁殖の程度 (0,0)
5ヶ月連続でブラジルチドメグサの漂着が観察されませんでした。ブラジルチドメグサの駆除活動が効果をあげているようです。
アサザは前月に引き続き浮葉を前年より展開しており復活の兆しが続いています。なお,新天地3候補もかなり被度を増していますので,新天地3と呼ぶことにします。
(2020年11月3日)天気 晴れ 水温17.9℃
ブラジルチドメグサの繁殖の程度 (0,0)
6ヶ月連続でブラジルチドメグサの漂着が観察されませんでした。しかし,となりの国担当の水路(通常は下)ではブラジルチドメグサが再び増殖し始めていました。
アサザは前月に引き続き浮葉を前年より展開しており復活の兆しが続いています。なお,移植場所と新天地の被度を合成すると,移植初期の被度を上回っているようです。
(2020年12月5日)天気 晴れ 水温13.1℃
ブラジルチドメグサの繁殖の程度 (0,0)
7ヶ月連続でブラジルチドメグサの漂着が観察されませんでした。これは,ブラジルチドメグサの繁殖の程度を表す方法を決定して記録を始めた2017年以降初めてのことです。楽観的な考察をすると,これはブラジルチドメグサの駆除活動に一定の成果が出始めている兆候であると言えるかもしれません。
アサザは水路の中央部側から葉身が消失していっています。しかし,前年より多くの茎が残っているようです。これも,楽観的に考えるとアサザ個体群の復活が続いていると言えるでしょう。
(2020年総括)
年後半にブラジルチドメグサの漂着が見られなかったのは,上流部での駆除活動が進んできていることを示唆しています。最初にブラジルチドメグサの花を観察したサザンクス筑後横の水路も現在はブラジルチドメグサの姿はありません。このようにブラジルチドメグサの駆除活動は部分的には成果をあげているようです。現在アサザ個体群継続観察を行っている県の水路でも一定の成果をあげつつあることから,次年からは,このコーナーのテーマを変更して,復活し始めているアサザ個体群に焦点をあてていく予定にしています。
リンク
Ph3筑後市アサザ個体群の周辺の生き物たち
R1-2 復活を続ける?筑後市のアサザ個体群
2021年
-
水際場所周辺のアサザ1月
水際場所周辺の護岸ブロックの隙間に入り込んで栄養体は来春の葉をつけていることがあります。
(筑後市,2021年1月3日) -
新天地のアサザ1月
新天地1及び3の護岸部の川岸はよく草刈りが行われているようです。水際部分ではまだ生きている茎がかなり多く枯れずに残っています。
(筑後市,2021年1月3日) -
移植場所の風景
一見何もないようにみえますが,すじ状に黒く見える場所では,アサザの葉が成長を始めています。
(筑後市,2021年3月9日) -
移植場所のアサザ3月
移植場所のアサザは3月に入ってもまだ,葉を水中に展開している状態です。
(筑後市,2021年3月9日) -
移植場所のアサザ4月
暖冬のためか例年より早く浮葉が展開していました。中央部おすじ状に見える部分が移植された場所の端です。
(筑後市,2021年4月5日) -
移植場所のアサザ5月-1
階段の左側では,移植場所での繁殖は殆どなく,両岸ににげだして栄養体が少しずつ増えている状態です。
(筑後市,2021年5月10日) -
移植場所のアサザ5月-2
階段の正面部分では中央溝の手前のラインが少しずつ復活しているようです。
(筑後市,2021年5月10日) -
移植場所のアサザ5月-3
階段の左側では少しずつ面的な展開がはじまっているようです。
(筑後市,2021年5月10日) -
新天地1の全景5月
対岸から見た様子です。アサザが被覆している長さは15m前後はあります。
(筑後市,2021年5月10日) -
新天地1の5月の様子1(左)
葉が水路中央へ向かって展開していく様子がわかります。
(筑後市,2021年5月10日) -
新天地1の5月の様子2(右)
現時点では,新天地1の被覆面積が県の水路では最大になっています。
(筑後市,2021年5月10日) -
新天地2の全景5月
対岸から見た様子です。ご覧の通りここは護岸部の草刈りがあまりされないようです。
(筑後市,2021年5月10日) -
新天地2の5月の様子
被覆面積は新天地の中で3番目ですが,成長は良好のようです。
(筑後市,2021年5月10日) -
新天地3の全景5月
対岸から見た様子です。草刈りがされるようになって急激に被覆面積が大きくなった気がしています。
(筑後市,2021年5月10日) -
新天地3の5月の様子
新天地1と新天地3の中間に位置しています。色々な場所でアサザの栄養体が確認されましたが,定着したのは全て同じ側です。
(筑後市,2021年5月10日) -
移植場所のアサザ8月
それぞれの浮葉の面積が大きくなっています。浮葉の被度も回復してきています。
(筑後市,2021年8月5日) -
ブラジルチドメグサの漂着
移植場所では,木屑と一緒にブラジルチドメグサの断片が数十漂着していました。木屑の下にも多数あり,アサザが漂着物をせき止めた形です。
(筑後市,2021年9月5日) -
長雨の後のアサザ9月
長雨の後,特に新天地1のアサザがこのようにひどくやられていました。
(筑後市,2021年9月5日) -
放置された釣り針
ブラジルチドメグサの駆除に使用しているたも網に放置されたルアーの針がひっかかってしまいました。
(筑後市,2021年9月5日) -
新天地1の10月
水深が浅くなったので,水辺にはヤナギタデなどが侵入して,新たな競争が生まれています。
(筑後市,2021年10月8日) -
移植場所のアサザ11月
アサザの葉がやや赤みを帯びてきています。鮮やかな緑色の葉はブラジルチドメグサです。
(筑後市,2021年11月6日) -
移植場所のアサザ12月
浮葉は殆どなくなっていました。移植場所の縁にあるコンクリートの壁にそって茎が残っています。
(筑後市,2021年12月5日) -
新天地1のアサザ12月
綺麗に草刈りがされていました。水の中も綺麗になっていましたが,アサザは無事でした。
(筑後市,2021年12月5日) -
新天地2のアサザ12月
新天地2のアサザの無事年が越せそうです。隣接していました特定外来種オオフサモは確認できませんでした。
(筑後市,2021年12月5日)
ブラジルチドメグサの駆除が一定の成果をあげているようですので,2021年からは,本来のテーマである筑後市のアサザ個体群の近況をレポートしていくことにします。
筑後市のアサザ個体群がいつ頃から存在しているのかはわかりませんが,現在県の水路と隣接する国の水路とに存在しています。いずれも,護岸工事のため一度堀りあげられたものが,水中にある花壇のような場所に植え戻されたものです。私達が関わっている県の水路のアサザ個体群は,2011年に彫りあげられ2012年に植え戻されたものです。私は2012年から,南筑後保健福祉環境事務所の依頼により,当時在任中の八女高校で筑後市のアサザ個体群(県の水路)の継続観察と系統の維持に関係することになりました。移植されたアサザ個体群は,最初の2~3年は葉を元気に展開していましたが,次第に衰退していきました。反面,一部の栄養体は側面の護岸された部分で繁殖を始めました。また,当時はネット(ブラジルチドメグサ侵入防止のため?)で仕切られていた部分の北側の護岸された場所で2014年秋にアサザの栄養体の繁殖が確認されました。この栄養体は一度2015年春に草取りにあいましたが,しぶとく生き残り短花柱花型の花をつけました。このように本来移植された場所から離れた場所で繁殖に成功した場所を新天地と呼んでいます。現在は発見された順に,新天地1,新天地2,新天地3と呼んでいる場所が存在しています。アサザは種子(種子が発達中の子房を含む)と栄養体とが水に浮いて移動ができます。新天地と呼んでいる場所はいずれも短花柱花型の花を咲かせていますが,その起源が種子であるか栄養体であるかは現時点では不明です。
筑後市での県の水路におけるアサザの繁殖の程度は,ブラジルチドメグサの繁殖の程度段階と同様な手法で段階化してみました。表示もブラジルチドメグサの繁殖の程度を参考にして
(移植場所とその周辺,新天地1,新天地2,新天地3,アサザ個体群全体)
と表示することにします。
[アサザの繁殖の程度段階化(私案)]
0 アサザの存在を確認できない
1 アサザの浮葉の被覆面積が1㎡未満
(水中の葉や生きている茎,地上葉などの存在は確認できる。)
2 アサザの浮葉の被覆面積が1㎡~2㎡未満
3 アサザの浮葉の被覆面積が2㎡~4㎡未満
4 アサザの浮葉の被覆面積が4㎡~8㎡未満
5 アサザの浮葉の被覆面積が8㎡以上
(2021年1月3日)天気 晴れ 水温10.0℃
ブラジルチドメグサの繁殖の程度 (0,0)
アサザの繁殖の程度 (1,1,1,1,1)
(2021年2月7日)天気 晴れ 水温14.0℃
ブラジルチドメグサの繁殖の程度 (0,0)
アサザの繁殖の程度 (1,1,1,1,1)
(2021年3月9日)天気 晴れ 水温15.4℃
ブラジルチドメグサの繁殖の程度 (0,0)
アサザの繁殖の程度 (1,1,1,1,1)
(2021年4月5日)天気 晴れ 水温17.5℃
ブラジルチドメグサの繁殖の程度 (0,0)
アサザの繁殖の程度 (2,2,2,2,3)
(2021年5月10日)天気 晴れ 水温21.0℃
ブラジルチドメグサの繁殖の程度 (0,0)
アサザの繁殖の程度 (3,5,4,4,5)
(2021年6月7日)天気 晴れ 水温22.9℃
ブラジルチドメグサの繁殖の程度 (0,0)
アサザの繁殖の程度 (2,5,3,4,5)
今回の観察で,移植場所の中央の深い溝が完全に埋まっているのが確認されました。今までこのコンクリートの溝が,アサザが水路中央に広がるための境界線としての働きをしていましたが,今後どのように変化するか注意深くみていく必要があります。
(2021年7月13日)天気 晴れ 水温28.0℃
ブラジルチドメグサの繁殖の程度 (3,4)
アサザの繁殖の程度 (3,4,2,2,5)
今回は久しぶりにブラジルチドメグサの栄養体が漂着し繁殖を開始していました。やはり,アサザの間に入り込み定着し繁殖しているものが多かったようです。アサザ個体群では移植場所のみが少しだけ勢力を拡大していました。
(2021年8月5日)天気 晴れ 水温30.0℃
ブラジルチドメグサの繁殖の程度 (0,0)
アサザの繁殖の程度 (4,4,2,2,5)
ブラジルチドメグサは,今回は漂着していませんでした。しかし,隣の国の水路では元気に繁殖しています。アサザ個体群では移植場所を中心に少しずつ勢力を回復してきているようです。
(2021年9月5日)天気 晴れ 水温26.1℃
ブラジルチドメグサの繁殖の程度 (1,3)
アサザの繁殖の程度 (3,3,2,2,4)
長雨のためか,ブラジルチドメグサの断片が多数流れ着いていました。水流が弱くなるアサザの周辺に多く留まっていました。アサザも順調に回復していたのですが,激流に浮葉を千切り取られているものが多くあり,結果として,浮葉の被度は低下していました。
(2021年10月8日)天気 曇り 水温24.2℃
ブラジルチドメグサの繁殖の程度 (1,2)
アサザの繁殖の程度 (3,3,2,2,4)
水深が少し深くなり,北側からの水路に水がありました。水は中央の水門から緩やかに流れだしていました。水流により新たに漂着したブラジルチドメグサを駆除しました。
アサザ個体群は順調な回復を予想していましたが,水路が浅くなったことにより他の植物が浅瀬に侵入してきたので,競争に負けた領域も見られました。
(2021年11月7日)天気 曇り 水温17.0℃
ブラジルチドメグサの繁殖の程度 (2,4)
アサザの繁殖の程度 (3,3,2,2,4)
南隣の国の水路の下流の堰が下ろされ,水面が連続していました。国の水路でもブラジルチドメグサが勢いよく繁殖し始めていましたが,観察している県の水路でも漂着したブラジルチドメグサが繁殖を開始した状態でした。
観察している県の水路のアサザ個体群は,早くも開花期間を終了している様子で葉はやや赤みを帯びてきていました。隣の国の水路のアサザ個体群はまだ多数の花が見られ,葉も青々としています。今回は,隣接する水路のアサザ個体群で大きな差が見られました。原因について,考えてみる必要があります。
(2021年12月5日)天気 晴れ 水温14.4℃
ブラジルチドメグサの繁殖の程度 (1,2)
アサザの繁殖の程度 (1,1,1,1,1)
水量が減少し南隣の国の水路とは水面が不連続になっていました。周辺の水路ではブラジルチドメグサが勢いよく成長しています。観察している県の水路でもあちらこちらに潜り込み繁殖を始めているものも見られました。相変わらず上流部からの栄養体の移入があったようです。
観察している県の水路のアサザ個体群は,もう殆ど浮葉がなくなっています。新天地1の周辺では,草刈りが行われていました。多少水中部分のアサザも除去されているようですが,根の部分は無事のようです。
ページ先頭へ
2022年
-
漂着したアサザ1月
現時点では元気に繁殖できそうな栄養体が水路入り口付近に漂着していました。
(筑後市,2022年1月9日) -
漂着したいブラジルチドメグサ1月
このような栄養体は,雨で水量が増加したときに漂着しているのかもしれません。
(筑後市,2022年1月9日) -
隣の水路のブラジルチドメグサ1月
ブラジルチドメグサは冬でも栄養成長できるので,漂着した栄養成長を放置すればやがてこのようになります。
(筑後市,2022年1月9日) -
隣の水路のブラジルチドメグサ5月(大繁殖)
今までで最大だと思います。
(筑後市,2022年5月4日) -
食害?の見られるアサザ(移植場所5月)
葉に食害のような痕がみられました。
(筑後市,2022年5月4日) -
新天地3のアサザ5月
前年よりも被度が小さいようです。
(筑後市,2022年5月4日) -
隣の国の水路のブラジルチドメグサ(除草剤散布?)
横から取水されています。黄色くかれているのは,除草剤の影響だと考えられます。
(筑後市,2022年6月4日) -
漂着したブラジルチドメグサ
太い茎から葉が出ているので,どこかで駆除されたものが流れ着いたのではないかと思います。
(筑後市,2022年7月7日) -
新天地3の果実形成
新天地3で始めて成熟した果実形成が観察されました。
(筑後市,2022年8月8日) -
食害?の見られたアサザ(移植場所12月)
根が水面近くまで浮き上がってきているので,水中葉の時に被食されたものと考えられます。
(筑後市,2022年12月3日)
2021年春は,アサザ個体群が復活していたのですが,夏以降断続的なブラジルチドメグサの侵入を許すことになり,全体としては一進一退という感じでした。また,ブラジルチドメグサ以外にも,水辺の植物との繁殖場所の競争も発生していました。筑後市のアサザ個体群は一度堀り上げられて,人為的に作られた場所に植え戻されたものに由来しています。移植当時は他に競争相手もいなかったですが,今は様々な植物が侵入しています。筑後市のアサザ個体群を維持するためには,他の生物とどのような折りあいをつけるかが問題になっているような気がします。しかし,当面はブラジルチドメグサの侵入を阻止しながら観察を続けていくしかなさそうです。
(2022年1月5日)天気 晴れ 水温11.1℃
ブラジルチドメグサの繁殖の程度 (1,1)
アサザの繁殖の程度 (1,1,1,1,1)
水量は減少したままで,南隣の国の水路とは水面が不連続になっていました。周辺の水路ではブラジルチドメグサが勢いよく成長しています。観察している県の水路では,前月ほどではないものの,数カ所で繁殖を始めているものも見られました。相変わらず上流部からの栄養体の移入があったようです。
観察している県の水路のアサザ個体群は,今のところ無事に冬が越せそうです。
(2022年2月11日)天気 晴れ 水温12.0℃
ブラジルチドメグサの繁殖の程度 (1,1)
アサザの繁殖の程度 (1,1,1,1,1)
水量は減少したままでしたが,堰の高さの関係で南隣の国の水路とは水面が連続になっていました。周辺の水路ではブラジルチドメグサが勢いよく成長しています。観察している県の水路では,雨が少ないためかブラジルチドメグサの漂着は僅かに4断片のみでした。
観察している県の水路のアサザ個体群は,浮葉はなくなっていました。
(2022年3月12日)天気 晴れ 水温17.2℃
ブラジルチドメグサの繁殖の程度 (1,1)
アサザの繁殖の程度 (1,1,1,1,1)
水量の大きな変化はなかったですが,ブラジルチドメグサの漂着は相変わらず続いています。観察している県の水路のアサザ個体群は,例年よりも成長が遅いように感じました。
(2022年4月3日)天気 晴れ 水温16.1℃
ブラジルチドメグサの繁殖の程度 (1,1)
アサザの繁殖の程度 (2,2,1,1,3)
水量の大きな変化はなかったですが,ブラジルチドメグサの漂着は相変わらず続いています。隣の国の水路では,ブラジルチドメグサが盛んに成長しています。観察している県の水路のアサザ個体群は,例年よりも成長が遅いようですが,やっと活動を始めた感じがしました。
(2022年5月4日)天気 晴れ 水温16.1℃
ブラジルチドメグサの繁殖の程度 (0,0)
アサザの繁殖の程度 (2,3,2,2,4)
水量の大きな変化はなく,ブラジルチドメグサの漂着も久しぶりにありませんでした。隣の国の水路では,ブラジルチドメグサがこれまでの最大級の繁殖をしていました。観察している県の水路のアサザ個体群は,例年よりも成長が遅いようで,浮葉はかなり展開していましたが,花はまだありませんでした。一部ミシシッピアカミミガメの食害のような痕がみられました。
(2022年6月4日)天気 晴れ 水温25.3℃
ブラジルチドメグサの繁殖の程度 (0,0)
アサザの繁殖の程度 (3,3,3,2,5)
水量が増加し,田植えの準備が始まっているようです。隣接する国の水路に横の水路から大量の水が取水され水面が連続していました。幸いなことに,ブラジルチドメグサの漂着はありませんでしたが,隣の国の水路では,ブラジルチドメグサが除草剤に耐えて生き残っていました。観察している県の水路のアサザ個体群は,例年よりも成長が遅いようですが,浮葉が少しずつ増加し,開花が始まっていました。ミシシッピアカミミガメの食害も心配です。
(2022年7月7日)天気 晴れ 水温25.9℃
ブラジルチドメグサの繁殖の程度 (1,1)
アサザの繁殖の程度 (4,4,4,4,5)
田植えも終了して,水深はほぼ元に戻っていました。水位は隣の国の水路と同じ状態が続いたためか,今回は久しぶりにブラジルチドメグサの漂着が見られました。国の水路でブラジルチドメグサの駆除作業が行われたので,その影響があったかもしれません。観察している県の水路のアサザ個体群は,少しずつですが被覆面積を増やしています。
(2022年8月8日)天気 晴れ 水温28.8℃
ブラジルチドメグサの繁殖の程度 (1,2)
アサザの繁殖の程度 (4,4,4,4,5)
再び隣接する国の水路に,横の水路から大量の水が取水され水面が連続していました。国の水路でブラジルチドメグサの駆除作業が再び行われ,今回はブラジルチドメグサの姿は国の水路からは消えていましたが,観察している県の水路には,ブラジルチドメグサが数カ所侵入していました。県の水路のアサザ個体群は,少しずつですが被覆面積を増やしています。また,新天地3で,始めて成熟した果実が見られました。
(2022年9月4日)天気 晴れ 水温25.8℃
ブラジルチドメグサの繁殖の程度 (1,1)
アサザの繁殖の程度 (4,4,4,4,5)
隣接する国の水路では,ブラジルチドメグサは引き続き目視では確認されないようになっていました。観察している県の水路には,ブラジルチドメグサが水路の排出口付近で1個体のみ確認されました。水辺は多くの雑草が生い茂っているので発見できていないものもある可能性は残ります。県の水路のアサザ個体群は,少しずつですが被覆面積を増やしているようにも見えますが,大きな変化はないようです。
(2022年10月2日)天気 晴れ 水温24.2℃
ブラジルチドメグサの繁殖の程度 (2,3)
アサザの繁殖の程度 (3,3,3,4,5)
隣接する国の水路では,水路周辺がきれいに除草されていて,ブラジルチドメグサも姿をけしていました。観察している県の水路はやや水位が上がり,再びブラジルチドメグサが侵入していました。県の水路のアサザ個体群は,被覆面積を広げきれず,残念ながら,花もまばらです。どうも,今年もあまり勢力を拡大することはできなかったようです。
(2022年11月5日)天気 晴れ 水温18.3℃
ブラジルチドメグサの繁殖の程度 (2,3)
アサザの繁殖の程度 (3,3,3,4,5)
観察している県の水路はやや水位が下がり,下流の水路とは水面が不連続になっていました西側の水路への少量の流出がありました。北側の水路からの流入については不明です。漂着してきたと思われるブラジルチドメグサもあり,また,前回の駆除をかいくぐったと思われる栄養体が茎を伸ばしはじめていました。県の水路のアサザ個体群は,被覆面積を広げきれず,残念ながら,花期も終了したもようです。
(2022年12月3日)天気 晴れ 水温12.0℃
ブラジルチドメグサの繁殖の程度 (1,2)
アサザの繁殖の程度 (1,1,1,1,1)
観察している県の水路は水位が下がったままで,下流の水路とは水面が不連続になっていましたが,前月同様,西側の水路への少量の流出がありました。北側の水路からの流入については不明です。漂着してきたと思われるブラジルチドメグサが少数ありました。また,前回の駆除をかいくぐったと思われる栄養体が茎を伸ばしはじめている場所が1ヶ所ありました。県の水路のアサザ個体群は,浮葉はほとんどなくなっていました。
また,食害?もありました。
ページ先頭へ
2023年
-
2023年1月1
観察している県の水路の全景です。奥が北。手前が移植場所。右側奥に,新天地2,新天地3,新天地1と続きます。
(筑後市,2023年1月8日) -
2023年1月2
奥側の様子。右側に新天地1,その手前が新天地3(写真の切れている部分),新天地2と続きます。
(筑後市,2023年1月8日) -
ブラジルチドメグサ3月(国の水路)
何も漂着しやすい構造がない場所から伸び始めているところが不気味です。
(筑後市,2023年3月4日) -
ブラジルチドメグサ4月(県の水路)
草に隠れた場所に根を伸ばしていました。根まで完全に除去できたかどうかは不明です。
(筑後市,2023年4月2日) -
元気がない?アサザ5月(移植場所)
比較的雨が多かった後のためか,浮葉の展開に元気がありません。食害?も
(筑後市,2023年5月5日) -
アサザ8月(移植場所)
久しぶりに移植場所のアサザが浮葉を大きく展開していました。
(筑後市,2023年8月27日) -
アサザ9月(移植場所)
被覆面積はそれほど広くありませんが,花が多く観察されました。
(筑後市,2023年9月23日) -
アサザ10月(移植場所)
前年よりも浮葉の成長は良いようです。
(筑後市,2023年10月15日) -
ブラジルチドメグサの大繁殖10月
短期間で順調に成長していました。根が法面にはっていないことから,漂着してきたものと考えられます。
(筑後市,2023年10月15日) -
ブラジルチドメグサ除去後の様子(新天地3)
中央から左側がブラジルチドメグサが覆い被さっていた部分です。アサザの浮葉の様子を比べてみてください。
(筑後市,2023年10月15日) -
アサザ11月(移植場所)
葉の一部に紅葉が始まり,冬の準備が進んでいるようです。
(筑後市,2023年11月18日)
(2023年1月8日)天気 晴れ 水温9.1℃
ブラジルチドメグサの繁殖の程度 (1,1)
アサザの繁殖の程度 (1,1,1,1,1)
前月同様,観察している県の水路は水位が下がったままで,下流の水路とは水面が不連続になっていました。西側の水路への少量の流出がありました。北側の水路からの流入については不明です。今回は漂着してきたと思われるブラジルチドメグサは1つのみでした。県の水路のアサザ個体群は,浮葉はみられず,水中葉もほとんどなくなっていました。
写真は水路の様子ですが,水面だけではなく,水中も例年になくまばらな感じがしました。
(2023年2月5日)天気 晴れ 水温10.4℃
ブラジルチドメグサの繁殖の程度 (0,0)
アサザの繁殖の程度 (1,1,1,1,1)
前月同様,観察している県の水路は水位が下がったままで,下流の水路とは水面が不連続になっていました。西側の水路への少量の流出がありました。北側の水路からの流入については不明です。今回は,久しぶりにブラジルチドメグサはありませんでした。県の水路のアサザ個体群は,前月同様,浮葉はみられず,水中葉もほとんどなくなっていました。
(2023年3月4日)天気 晴れ 水温15.4℃
ブラジルチドメグサの繁殖の程度 (0,0)
アサザの繁殖の程度 (1,1,1,1,1)
前月同様,観察している県の水路は水位が下がったままで,下流の水路とは水面が不連続になっていました。西側の水路への流出が前月よりも増加していました。県の水路では,ブラジルチドメグサはありませんでしたが,下流の国の水路ではブラジルチドメグサが伸び始めていました。県の水路のアサザ個体群は,葉がしだいに成長して一部は水面に達していました。
(2023年4月2日)天気 晴れ 水温19.6℃
ブラジルチドメグサの繁殖の程度 (2,2)
アサザの繁殖の程度 (1,1,1,2,3)
前月同様,観察している県の水路は水位が下がったままで,下流の水路とは水面が不連続になっていました。西側の水路への流出は前月と同程度でした。下流の国の水路ではブラジルチドメグサが駆除されていました。県の水路のブラジルチドメグサは,1ヶ所で繁殖を始めていました。2ヶ月連続でブラジルチドメグサが観察されていませんでしたので,比較的大きな栄養体が漂着したか,もしくは,駆除をかいくぐって休眠いていた栄養体が繁殖を開始したのではないかと思われます。県の水路のアサザ個体群は,葉がしだいに成長して少しずつ水面を覆い始めていました。
(2023年5月5日)天気 晴れ・曇り 水温21.4℃
ブラジルチドメグサの繁殖の程度 (1,1)
アサザの繁殖の程度 (1,1,1,2,3)
前月同様,観察している県の水路は水位が下がったままで,下流の水路とは水面が不連続になっていました。西側の水路への流出は前月と同程度でした。県の水路のブラジルチドメグサは,1ヶ所で繁殖を始めていました。駆除をかいくぐっていた栄養体が繁殖を開始したのではないかと思われます。県の水路のアサザ個体群は,前日の雨の影響か?浮葉に元気がないようです。強い雨粒があたると葉の表面がダメージをつけ,あまり水をはじかなくなるのかもしれません。このダメージが梅雨の時期の繁殖を抑える原因の1つかもしれません。
(2023年6月3日)天気 晴れ・曇り 水温24.8℃
ブラジルチドメグサの繁殖の程度 (1,2)
アサザの繁殖の程度 (1,1,1,1,3)
前月同様,観察している県の水路は水位が下がったままで,下流の水路とは水面が不連続になっていました。西側の水路への流出は前月よりやや速くなっていました。県の水路のブラジルチドメグサは,駆除をかいくぐっていたと思われる栄養体1つ及び漂着した思われるものが数個体ありました。県の水路のアサザ個体群は,例年よりも浮葉が少なくミシシッピアカミミガメなどによる食害ではないかと考えられます。なお,水路横でカルガモが巣を構えていました。カルガモは雑食性ということで,アサザの食害に関係しているかもしれません。
(2023年7月4日)天気 曇り 水温23.2℃
ブラジルチドメグサの繁殖の程度 (1,1)
アサザの繁殖の程度 (1,1,1,1,2)
前月同様,観察している県の水路は水位が下がったままで,下流の水路とは水面が不連続になっていました。西側の水路への流出は前月より速くなっていました。県の水路のブラジルチドメグサは,漂着したと思われる栄養体が2個体ありました。県の水路のアサザ個体群は,大雨の影響もあり被度が小さくなっていました。開花も2つのみでした。
(2023年8月27日)天気 晴れ 水温28.1℃
ブラジルチドメグサの繁殖の程度 (1,2)
アサザの繁殖の程度 (3,5,3,3,5)
隣接する国の水路に,横の水路から大量の水が取水され水面が連続していました。国の水路でブラジルチドメグサの駆除作業が再び行われ,今回はブラジルチドメグサの姿は国の水路からは消えていましたが,観察している県の水路には,ブラジルチドメグサが3カ所に侵入していました。県の水路のアサザ個体群は,久しぶりに被覆面積を増やし,それぞれの葉1枚1枚の大きさが大きくなっています。水路内をなぜか大型のコイが多数泳いでいました。
(2023年9月24日)天気 晴れ 水温24.7℃
ブラジルチドメグサの繁殖の程度 (1,2)
アサザの繁殖の程度 (4,5,3,3,5)
隣接する国の水路に,前月と同様に横の水路から大量の水が取水され水面が連続していました。観察している県の水路には,ブラジルチドメグサが2カ所に侵入して,その1つが展開しているアサザの間に侵入していて,駆除するのが大変でした。駆除が十分でない可能性もあります。観察しているアサザ個体群は,被度を少しずつ増やしているようですが,食害?の痕が気になります。
(2023年10月15日)天気 晴れ 水温22.8℃
ブラジルチドメグサの繁殖の程度 (4,4)
アサザの繁殖の程度 (4,5,3,3,5)
隣接する国の水路に,横の水路からの大量の水の取水は終了していましたが,水面がまだ連続していました。観察している県の水路には,新天地3で漂着したブラジルチドメグサが,アサザに覆い被さっていました。幸い,根は法面の土壌には達していませんでした。前回の駆除から3週間程度で,これ程繁殖するのは脅威です。観察しているアサザ個体群も,被度を少しずつ増やしているようで,ブラジルチドメグサとアサザは,ともに栄養成長に適した季節に入っているのかもしれません。
(2023年11月19日)天気 晴れ 水温15.0℃
ブラジルチドメグサの繁殖の程度 (3,4)
アサザの繁殖の程度 (5,5,4,5,5)
隣接する国の水路に,横の水路からの大量の水の取水は終了していましたが,水面がまだ連続していました。ブラジルチドメグサも繁殖を再開していました。観察している県の水路には,新天地3で前回の駆除を逃れたと思われるブラジルチドメグサが繁殖を再開していました。また,漂着したと思われる栄養体もかなり広がっていました。観察しているアサザ個体群も,被度は少し増えたようですが,浮葉が紅葉しているものが見られました。前年に比べ,ミシシッピアカミミガメなどの食害は減少しているようです。
(2023年12月9日)天気 曇り 水温14.1℃
ブラジルチドメグサの繁殖の程度 (1,2)
アサザの繁殖の程度 (1,2,2,3,4)
隣接する国の水路に,横の水路からの取水は減少していて,水面はすぐ横の水路とは連続していましたが,下の水路とは不連続になっていました。繁殖を再開していたブラジルチドメグサは駆除されていました。観察している県の水路には,漂着したと思われる栄養体が数ヶ所で繁殖を始めていました。観察しているアサザ個体群も,浮葉が枯れ始め被度はかなり減少していました。
2024年
(2024年1月8日)天気 曇り 水温11.6℃
ブラジルチドメグサの繁殖の程度 (1,1)
アサザの繁殖の程度 (1,1,1,1,1)
隣接する国の水路に,横の水路からの取水が続いており,下流の堰の高さの調節もあり,下流の水面と県の水路の水面が同じになっていました。また,県の水路の北側からの流入も確認されました。ブラジルチドメグサの姿は見えませんでしたが,西側の流出口に栄養体が1つのみ確認されました。観察しているアサザ個体群も,浮葉がほぼなくなり,水中葉のみになっていました。
(2024年2月11日)天気 晴れ 水温12.0℃
ブラジルチドメグサの繁殖の程度 (0,0)
アサザの繁殖の程度 (1,1,1,1,1)
前月と同様に隣接する国の水路に,横の水路からの取水が続いており,県の水路の北側からの流入も続いていました。流速もやや速くなっていました。幸い,ブラジルチドメグサの姿は見えませんでした。観察しているアサザ個体群も,浮葉はなくなり,水中葉もほとんど観察されませんでした。
(2024年3月2日)天気 晴れ 水温13.2℃
ブラジルチドメグサの繁殖の程度 (0,0)
アサザの繁殖の程度 (1,1,1,1,1)
前月とは異なり隣接する国の水路に,横の水路からの取水はなく,上流の水面と下流の水面とは不連続になっていました。しかし,県の水路の北側からの流入も僅かに続いていました。流速はほとんどなくなっていました。幸い,ブラジルチドメグサの姿は見えませんでした。観察しているアサザ個体群も,浮葉はなくなり,水中葉はようやく成長を始めた状態でした。
(2024年4月6日)天気 曇り 水温18.9℃
ブラジルチドメグサの繁殖の程度 (0,0)
アサザの繁殖の程度 (4,5,3,4,5)
前月に続き隣接する国の水路に,横の水路からの取水はなく,上流の水面と下流の水面とは不連続になっていました。しかし,県の水路の北側からの流入も僅かに続いていました。流速はほとんどなくなり,ブラジルチドメグサの姿は見えませんでした。観察しているアサザ個体群は,浮葉がまだ赤みを残していましたが,展開して広がり始めていました。
(2024年5月5日)天気 曇り 水温22.9℃
ブラジルチドメグサの繁殖の程度 (0,0)
アサザの繁殖の程度 (5,5,4,4,5)
前月に続き隣接する国の水路に,横の水路からの取水はなく,上流の水面と下流の水面とは不連続になっていました。流速はほとんどなくなり,ブラジルチドメグサの姿は見えませんでした。観察しているアサザ個体群は,葉を展開し全ての箇所で開花していました。
(2024年9月1日)天気 晴れ 水温27.0℃
ブラジルチドメグサの繁殖の程度 (2,4)
アサザの繁殖の程度 (4,4,4,4,5)
台風などの雨により水量は増加しており,水も静かに流れていました。ブラジルチドメグサも多く漂着していましたが,大繁殖には至っていませんじした。約4カ月間駆除活動ができていませんでしたので少し安心しました。今回は釣り人及び道具の関係ですべてブラジルチドメグサを駆除することはできませんでした。観察しているアサザ個体群は,やや夏で勢力が弱まっている様子です。
(2024年10月6日)天気 晴れ 水温26.0℃
ブラジルチドメグサの繁殖の程度 (5,5)
アサザの繁殖の程度 (4,5,4,4,5)
雨が少なかったせいか水は濁っていました。ブラジルチドメグサは前回駆除できなかった場所以外でも大繁殖していました。特にアサザ群落の周辺で大繁殖をしています。元々新天地にはアサザも漂着したと考えられますので,ブラジルチドメグサの漂着しやすい条件が揃っている場所の可能性もあります。観察しているアサザ個体群は,ブラジルチドメグサの大繁殖には劣りますが,それないにがんばって開花していました。
(2024年10月24日)天気 晴れ
前回活動で駆除できなかったブラジルチドメグサの駆除のために,1ヶ月で2回目の駆除を行いました。地元の人達の働きで法面の草刈りとブラジルチドメグサの大群落の駆除は実施されたようです。おかげで,今回はブラジルチドメグサの駆除作業の後は,ブラジルチドメグサの姿は肉眼で確認できない程度まで駆除することができました。
(2024年11月9日)天気 晴れ 水温19.3℃
ブラジルチドメグサの繁殖の程度 (1,2)
アサザの繁殖の程度 (4,5,3,4,5)
ブラジルチドメグサはやはり小さな栄養体からの繁殖が複数始まっていました。今回,その量は一回で駆除できる程度でした。観察しているアサザ個体群は,季節の変化が急激に現れたように黄葉をしているものが目立ちました。花期はほぼ終わりのようです。
(2024年12月1日)天気 晴れ 水温14.4℃
ブラジルチドメグサの繁殖の程度 (1,1)
アサザの繁殖の程度 (3,3,2,2,4)
ブラジルチドメグサはやはり小さな栄養体がアサザの間に漂着していました。観察しているアサザ個体群は,季節の変化が急激に現れたように黄葉をしているものが目立つものの,例年の12月よりも緑の葉がしっかりと残っていましたが,花期は終了していました。
R2 八女の自然に親しむ会2019年~(H,S)
2019年
-
セイヨウカラシナの菌瘤1
(八女郡広川町,2019年4月21日)
-
セイヨウカラシナの菌瘤2
(八女郡広川町,2019年4月21日)
-
アゲハモドキ
蝶のようにみえますが,これは蛾です。
(八女市黒木町,2019年5月12日) -
ジャケツイバラ
種名にイバラとありますが,マメ科です。
(八女郡広川町,2019年5月12日) -
漁巣ブロック(漁苑)
ナマズが隠れた場所。水棲動物の隠れ家として機能しそうです。
-
地衣植物
中央部の暗緑色の塊がコバノアオキノリでまわりの淡緑色のものがレプラゴケのなかま(種名未同定)です。(八女市立花町,2019年6月9日))
-
飯江川の河川拡幅工事
カワラニンジン(右)の写真のバックです。
(みやま市,2019年7月28日) -
コナアカハラムカデゴケ
橙赤色の部分は髄層で,食害されたものです。左下隅の長楕円の構造はミノガ?です。
(みやま市,2019年7月28日) -
アサギマダラ♂
コアカソで翅を休めている所。♂は後翅の下部に黒い斑(性徴)があります。
(八女市,2019年10月13日) -
ツクシアザミ
アザミの仲間で花(頭花)が横を向くのが特徴だそうです。
(八女市,2019年10月13日) -
ニホンミツバチ?
ニホンミツバチは腹部の上の方まで,このように黒いのが特徴とされてますが,大きさはセイヨウミツバチと同じ程度でした。
(筑後市,2019年11月10日) -
コシロノセンダングサ?
北九州市で当時よくみかたコシロノセンダングサに形態がよく似た個体。公園の中ですからどこからきたかは判りません。
(筑後市,2019年11月10日)
<4月21日>八女郡広川町水原広川ダム周辺
今回の話題は「防蛾灯」・「カッチョ」・「セイヨウカラシナの異常成長」です。
果樹園の横を歩いていると照明装置が点在していました。農家の方に尋ねますと夜蛾を防ぐ照明だとのこと。「え,夜蛾は照明に集まるのでは?」ということで宿題に。帰ってネットで調べてみますと,確かにそのような商品がありました。メーカーの説明によると夜活動する蛾は日光の500〜600nm付近の波長の光を昼間と認識するらしく,LEDランプを使用して夜間にその波長の光で照明すると,夜蛾は昼と勘違いして行動しなくなり,夜蛾の被害が減るそうです。(聞いたことありましたね)
ネットで「カッチョ・鳥・方言」で検索をかけると,「こちら(福岡)では『カッチョ』って言っていましたが,本来の名前はシロハラ(白腹)って・・・」となどという内容が上位にでてきます。いくつか下に糸島弁ブログというのがあり,「久留米八女などでつぐみ「筑後方言辞典:松田康夫:久留米郷土研究会」という引用記事がありました。久留米在住の私は「カッチョ」はツグミのことと思っていました。しかし,ネットではどうもシロハラが優勢のようです。八女の自然に親しむ会でも,シロハラが優勢でした。私個人の考えでは,鳥の専門家でない人々の呼び名に1種の鳥を当てるのは無理があると思います。地面付近で観察できるツグミ・シロハラ位の色・大きさの鳥程度でいいのではないでしょうか。
オリーブ畑の脇にセイヨウカラシナが咲いていました。よく見ると花の一部に異常成長が見られました。虫瘤かと思い割ってみましたが何もでてきません。ネットで検索すると白さび病菌
(Albugo)の仲間が引き起こす菌瘤であることがわかりました。
<5月12日>八女市黒木町大淵松瀬ダム周辺
今回の話題は「アゲハモドキ」と「ミズカマキリ」です。
ダム湖周辺を散策していると「あれは何ですか。」と尋ねられましたが,「蛾ですよ。」と答えたものの名前がでてきません。友人に尋ねると「アゲハモドキ」という答えが帰って来ました。メンバーの一人は何と幼虫を育てたことがあるそうです。ネットで幼虫の写真を見ましたがとても育ててみようとは思いませんでした。アゲハモドキは,有毒物質を保有するジャコウアゲハに擬態することで,鳥などからの捕食を免れているとのことです。この擬態がどれほど生存率に貢献しているかはわかりませんが,アゲハモドキの幼虫の姿は,ヒトを遠ざける効果は十分にありそうに思えました。
「え,ミズカマキリが県の絶滅危惧種?」これはどうも私の聞き間違いで,調べてみると県の準絶滅危惧種とのことでした。キャンプ場の近くの水田に水が入れられており,ミズカマキリが悠々と泳いでいます。なんと,ヒルも泳ぐんですね。こちらは,初めて見ました。小さい頃,池や水たまりで裸足になって遊んでいると,何だかかゆいと思うと,いつもヒルが血を吸っていました。ヒルの思いがけない素早さに何か納得させられました。それにしても,あんなにたくさんいたミズカマキリが,今は準絶滅危惧種とは驚きです。聞けば,このあたりの水田はあまり農薬を使わないそうです。25年位前に野外で始めてみたホウネンエビやカブトエビのいた田んぼ(飯塚市)もそうでしたね。
<6月9日>八女市立花町千間土居公園周辺
今回の話題は,「漁巣ブロック」と「地衣植物豆知識」です。
公園南側の小さな水路横を歩いていると,大きなナマズが泳いでいるのが見えました。聞けば,コイとナマズは今が恋の季節だそうで,ナマズは昔田んぼの中まで入り込んで産卵していたそうです。別の水路ではコイが体高より浅い水路を登っていました。鯉の滝登りをイメージさせる光景です。ナマズを見ていると2尾いて,ともに穴のあいた護岸ブロックの中へ消えていきました。「あの2尾はきっとカップルだろうな。」などと話ながら,話題はこのブロックの方へいきます。「こんな護岸工事は見たことがありませんね。」と話しながら,ナマズがでてこないかとカメラを構えていましたが,残念でした。自宅でこの護岸ブロックについて検索してみると漁巣ブロックで「漁苑」と呼ばれているようです。「漁苑」の効果に関する論文も記載されているようですが,短時間の観察でも魚類の棲息や生態系の安定に対して一定の効果はあるように思います。
矢部川の周辺にはクスノキの大木が多くあります。川の周りで空中湿度がある程度保たれているせいか,樹皮には多くのコケ・キノコ・地衣植物がついています。私がこの仲間について種名を語ることは百年早いと思いますが,幸いメンバーの一人にミニ専門家がいますので,彼の説明を伝えることはできます。写真にはいくつかの種が写し込まれているかもしれませんが,目立つのは暗緑色のものと淡緑色のものです。共に地衣植物で,暗緑色のものがコバノアオキノリで淡緑色のものがレプラゴケのなかま(種名未同定)だそうです。地衣植物は菌類と藻類の共生です。植物体(地衣体)の色は,主に菌類と共生している藻類の種類で決まるそうで,暗緑色のものはランソウと淡緑色のものは緑藻とそれぞれ共生しているそうです。しかし,オレンジ色もありましたね。
<7月28日>矢部川・飯江(はえ)川合流点付近周辺(みやま市高田町堀切)
今回の話題は,「川幅拡幅工事」と「地衣植物豆知識」です。
矢部川・飯江川合流点付近周辺では,川幅拡幅工事が実施されていました。工事の経緯や目的については,不勉強なので触れませんが,そこは,干潟になっておりムツゴロウ・トビハゼなどの棲息場所になっています。話題になったのが,干潟に差し込まれた物干し竿のような棒です。必ず2本一組で風に揺れて時折甲高い音を発生していました。「あれは,干潟の動物を野鳥から守るため」や「船に浅瀬を知らせる目印」などの仮説がでましたが,現時点では,正解をゲットしていません。
昼食にお借りしたお寺には,多くのコケや地衣植物がありました。写真はコナアカハラムカデゴケという地衣植物で珍しいそうです。コケガなどに食害されると橙赤色の髄層が顔を見えます。この髄層の色が和名の由来だそうです。コケガと思われる幼虫は見つかりませんでしたが,コケをまとった1㎝程度ミノガ?が多数いました。
ページ先頭へ
<10月13日>源流の森への林道(標高900m付近,八女市矢部村北矢部)
今回の話題は,「アサギマダラの移動」と「帰化植物の侵入」です。
アサギマダラは近年遠距離を移動していることが解明されました。そのため,従来の山と里の間で移動しているという考え(小さな領域での繁殖)は否定的な意見が大勢のようです。しかし,この小さな領域での繁殖は本当にないのでしょうか。小さな領域での繁殖を完全に否定するのは極めて困難ですが,証明するのも容易ではなさそうですね。そこで,観察した結果だけを報告しますと,昼頃の観察で数個体目撃しました。他の会員の話によると9月には近隣の場所で多数見かけたとのことでした。
身の回り環境には外来の植物で定着したもの,帰化植物で溢れています。しかし,この林道には,明るい入り口付近にセイタカアワダチソウがあっただけで,帰化植物が侵入していませんでした。その理由としてまず考えられるのが,ヒトや車の侵入が少ないことです。活動中通った車はゼロ,ヒトは1人です。帰化植物の多くはセイヨウタンポポのように風で運ばれてくると思っている方が多いと思いますが,かなりの種子がヒトや車に付着した泥と一緒にやってきます。ヒトが帰化植物の移動を助けている訳です。しかし,たとえ進入できたとしてもそこに待っているのは帰化植物とっては悪い環境です。多年草がしっかり根をはり,周辺の木本も小さくはありませんので,発芽や初期の成長に必要な光が十分にはありません。このような帰化植物にとっての悪い環境が続くことを祈りたいものです。
<11月10日>筑後市広域公園 (筑後市津島)標高8m前後
今回の話題は「ニホンミツバチ」と「コシロノセンダングサ」です。
ヒマワリの花を訪れているニホンミツバチ風の個体の写真を撮っていますと,会員の一人が「それはニホンミツバチではないですよ。ニホンミツバチはもう少し小型です。私,家で飼っていましたから。」と声をかけられました。そこで,山田養蜂所の方から伺ったことを話すと,「確かにセイヨウミツバチとニホンミツバチは共同生活をします。私もニホンミツバチの群れで女王が死去した集団をセイヨウミツバチと一緒にしたら,共同生活をしていました。」とのことでした。双方の主張で共通なことは,「ニホンミツバチの女王蜂が存在しない環境下であれば,ニホンミツバチはセイヨウミツバチと共同生活をする。」ということですかね。ミツバチの他の群れに対する排他性にはそれぞれの女王バチが発する化学物質が関係しているかもしれません。
(追加修正分)
藤丸篤夫著の「ハチハンドブック」の記載によれば,ニホンミツバチは「(セイヨウミツバチと比較すると)全体に黒味が強い。腹節に黄白色帯があり,しま模様がはっきりしている。・・・正確には後翅の翅脈の違いで識別する。」とあります。両種の翅脈の写真が掲載されていて,後翅の外側の翅脈がセイヨウミツバチは1本ですが,ニホンミツバチは翅脈が二股に分かれていて下のものは翅の途中までで切れているようです。これは,よほど上手に写真を撮らないと判別はできないでしょう。両種は,採集してみれば違いがわかることになりますが,写真だけではかなり困難です。この両種の違いについては,後日参考のページで整理することにします。
<修正>2022年12月31日
私はもう三十数年も前に北九州市で,高校生と一緒にセンダングサ属の分布調査をしたことがあります。調査の対象としたのが,センダングサ,コセンダングサ,コシロノセンダングサ,アメリカセンダングサ及びタウコギの5つです。コセンダングサとコシロノセンダングサとは広義のコセンダングサの変種の関係にあるとされています。当時の調査結果を記憶の範囲で紹介しますと,
① センダングサは都市構造の周辺部分に多く,コセンダングサとコシロノセンダングサは宅地化が進んでいる場所で多く見つかった。
② アメリカセンダングサは比較的水辺に近い場所で多く発見されたが,タウコギは発見できなかった。
です。当時問題になったのが,
③ コセンダングサには,白い舌状花が未発達なタイプが見られる。(これは,現在アイノコセンダングサと呼ばれているものですが,一応コセンダングサに分類しました。)
④ 北九州市の範囲内では,センダングサには形態だけで区別できる二つのタイプが見られた。(一応,センダングサA・センダングサBとして区別しました。)
です。この時に作成した分布地図は北九州の自然誌博物館に保存されているはずです。
なお,時を同じくして「緑の国政調査」なるもの(植物の分布調査)が実施され,生徒の一人が自分たちの調査結果を報告していました。センダングサ属では,センダングサ及びタチアワユキセンダングサ(オオバナノセンダングサ)が対象になっていました。私も結果に興味がありましたので,調査結果をまとめた「自然環境基礎調査用メッシュ地形図」と言われるものを関係部分だけ購入しました。結果は驚くべきものでした。センダングサが広く分布し,タチアワユキセンダングサ(オオバナノセンダングサ)も少なからず分布しているということになっています。まとめた日付は1985年12月18日となっています。噂によれば,沖縄などの南の島に分布しているタチアワユキセンダングサ(オオバナノセンダングサ)の北上を調べることが調査の目的の一つであったとのことでした。私も多くの人を巻きこんで分布調査をすることの難しさを知りました。ちなみに,私が福岡県で初めてタチアワユキセンダングサ(オオバナノセンダングサ)を見たのは,21世紀の初めごろ志賀島においてです。現在は,大牟田市の三池港に定着しているようです。
きっかけは覚えていないのですが,幸いなことに長田武正先生にセンダングサ属について相談する機会がありました。センダングサA及びセンダングサBについては自分にも判らないので別の先生と国立科学博物館にある洋書とを紹介していただきました。一応私も努力はしてみたのですが,現在もこの問題の解決に至っていません。なお,タウコギについても分布情報をいただき大分県まで出向き種子を採集し発芽実験などを試みました。
前振りが長くなりましたが,本題はコシロノセンダングサです。分布調査をした当時は,コセンダングサ(アイノコセンダングサと呼ばれているものを含む)とコシロノセンダングサとは不連続と思われる区別がありました。コシロノセンダングサは明瞭な白い舌状花を展開するだけではなく,果実も統計的に比べると明らかに小ぶりでした。葉も明確な差とはいかないまでも9割以上の確度で区別できました。しかし,筑後市とその周辺ではコシロノセンダングサの当時の形態を示している個体をほとんど見かけません。見かけるのは,アイノコセンダングサに近い感じがするもので,「アイノコセンダングサの舌状花が比較的よく展開したもの」という感じのものです。その理由について考えてみますと,
① 当時の北九州市には,コシロノセンダングサの1タイプのみが広がっていた。
(コシロノセンダングサの変種内には,現在の筑後に見られるようなものが元々あった。)
② コセンダングサ及びコシロノセンダングサ間の交雑が進み,その交雑の結果コシロノセンダングサに近い現在のタイプになった。
③ コセンダングサの中に,元々温度などの環境条件の違いで舌状花を展開する変異が含まれていた。
などです。③の舌状花をつけることが環境条件で変化する要素があるとすれば形態のみで種(変種)を同定するのには厄介です。しかし,1個体のアイノコセンダングサの舌状花の段階にも様々あり,可能性としては捨てられません。センダングサ属の分類もタンポポと同様に何をもって一つの種とするかは大変難しいですね。
余談ですが,福岡のある植物研究グループが作成した「コバノセンダングサ」と同定された標本を見せていただいたことがありますが,長田武正先生の帰化植物図鑑や私がよく参考にさせてもらっているウェブサイトの写真とは明らかに異なっていました。私達もコバノセンダングサを探していましたので残念でした。長田武正先生から「ゴバノセンダングサは実物を一度見ればすぐに判りますよ。」と言われましたが,後日,岐阜県で初めてコバノセンダングサを見る機会があり,長田武正先生がおっしゃられた通りでした。「百聞は一見に如かず」で,その時初めて「私たちの分布調査では,タウコギとコバノセンダングサは発見していない。」ということを自信をもって言えるようになりました。
今回は,時間をかけて問題の解決に取り組もうという人が誰もいないだろうというテーマを2つ取りあげました。なお,コシロノセンダングサ?の写真は,当時北九州市で見かけていたタイプに非常に近い感じがしたものを載せました。
2020年
-
オオシロカラカサタケ
毒があるキノコです。左は裏面です。
(筑後市,2020年9月13日) -
アレチイボクサ1
刈り取りがされていない時の開花の様子です。
(筑後市,2020年9月13日) -
アレチイボクサ2
草刈り後,しぶとく開花している様子です。
(筑後市,2020年9月13日) -
タウコギ
花のまわりに葉のようにみえるものは,総包片と呼ばれるものです。
(由布市,2020年9月21日) -
アメリカセンダングサ
タウコギに似ていますが,頭花はやや小さく茎は細く紫色が強く出ることが多いようです。
(由布市,2020年9月21日) -
メスグロヒョウモン♀
ケイトウの花に吸蜜に訪れていました。
(八女市,2020年10月11日) -
コフキカラタチゴケ
サルオガセの仲間で,排気ガスなどの影響で町中ではあまり見かけられなくなっているそうです。
(八女市,2020年10月11日) -
カバマダラ1
南方から飛来してくる迷蝶です。アレチハナガサで吸蜜しています。
(柳川市,2020年11月8日,Y,T) -
カバマダラ2
セイタカアワダチソウで吸蜜しているところ。比較的多くの花を訪れているようです。
(柳川市,2020年11月8日) -
ルリウラナミシジミ♀
2020年多くの場所で確認されている迷蝶です。アレチハナガサで吸蜜していました。
(柳川市,2020年11月8日,Y,T) -
ウラナミシジミ
こちらは在来種です。後翅の黒斑と白帯の形を比較すると区別できます。
(柳川市,2020年11月8日)
<9月13日>筑後市広域公園 (筑後市津島)標高8m前後
コロナ禍で,久しぶりの野外活動でした。この会のいいところは,自分で調べてもわからないことを他の会員に尋ねられることです。私は伐採したクロガネモチにキクラゲとともに生えてくる褐色のゼリー状のキノコ?が気になっていたので尋ねると,「ヒメキクラゲだろう。」ということになりました。逆に,宿題もいただきました。自宅の水槽の中に突然生えてきた水草を預かって名前を調べることになりました。調べてみると,絶滅危惧種の「ヒシモドキ」でした。絶滅危惧種のヒシモドキがどのようにして,大牟田市にある会員の水槽に到着したのかは,次回の例会で尋ねることにします。
<追記>10月の例会で,会員の方と相談した結果,現時点では,在来種のヒシモドキに酷似しているが,葉の形態や裏面が紫色でないところが気にかかるので,継続観察をして来年まで決論をだすのを延期しようということになりました。
今回の話題は「オオシロカラカサタケ」と「アレチイボクサ」です。
今年は各地で毒キノコの報告が相次いでいるようですが,よほどキノコに詳しい人以外は野外で採集したキノコは食さない方がいいと思います。私もキクラゲ以外は食べたことはありません。「オオシロカラカサタケ」は別にはでな色はしていませんが,毒キノコだそうです。キノコをよく食べている会員の説明によると,写真のようにキノコの柄の部分にひだがあるものは毒キノコが多いそうです。ひだがなければ食べられるという訳ではありません。なお,マツタケや他の美味しいキノコの採集場所は他人には教えないそうです。
アレチイボクサは近年確認された熱帯アジア原産の外来種のようです。話題になったのが芝刈りの後で開花していたことです。アレチイボクサはツユクサ科ですが,芝の代用品として使えるのではないかという意見がでました。まだ,新参の外来種ですが,その内にどこででもみかけるようになる日は,そう遠くない気がしました。
<9月21日>番外編 タウコギを探しに大分県へ
昨年センダングサの記事を書いたら,故長田武正先生のことを懐かしく思い出しました。三十数年前に教えていただいた大分県の分布地に,まだタウコギは無事生き延びているだろうかが気になります。会員の皆さんも福岡県では見かけないと言っています。県によっては,絶滅危惧種に指定しているところもあるそうです。コロナ禍が続いていますので,日帰りで出かけました。結果は,田んぼの脇にまだ無事たくましく生き残っていました。不思議なことに,横の水路には,アメリカセンダングサがはびこっていましたが,田んぼの脇ではタウコギが優勢でした。タウコギが減少したのはどうも除草剤が関係しているようなので,観察地周辺ではあまり除草剤を使用していないかもしれないなと思いました。絶滅危惧種は薬剤と生態系の変化が大きく関わっているようです。案外,トノサマガエルがまだ棲息している場所で,薬剤使用の少ない場所を探すと,筑後でもまだタウコギが棲息している場所があるかも知れませんね。
<10月11日>八女市黒木町大淵椎窓標高160m前後
今回の話題は「メスグロヒョウモン」と「コフキカラタチゴケ」です。
ヒョウモンチョウの仲間の翅は橙色の地に豹柄の紋が入ります。メスグロヒョウモンでは,雄は普通に豹柄ですが,雌は焦げ茶色の地に白い模様が入ります。私は写真撮影時はてっきりクロコムラサキと思っていました。クロコムラサキはコムラサキの暗色タイプで数が少ないようです。友人からは「クロコムラサキはコムラサキの形をしているよ。」との指摘を受けました。クロコムラサキとメスグロヒョウモンの雌は色や模様は類似していても,クロコムラサキはタテハチョウの仲間なので,翅の形状が異なります。しかし,素人目にはメスグロヒョウモンの雌とクロコムラサキの雌は非常に似ています。
別のページの「ツマグロヒョウモンの擬態と蛹の色」のコーナーで,ツマグロヒョウモンの擬態について触れました。このテーマはネットでも簡単に検索できます。メスグロヒョウモンの雌とクロコムラサキの雌との類似度は,ツマグロヒョウモンの擬態で話題にされる種よりも遥かに高いように素人目には思われます。しかし,私の検索能力では,メスグロヒョウモンの雌とクロコムラサキの雌の擬態という解説は発見できません。その理由として,「非常にマイナーなテーマなので,ネットの検索にはかかりにくい。」ことも考えられますが,「科学的な研究には不向きなテーマ」ではないかと考えます。やはり,「擬態とは,何かに類似していることが,生物学的な適応に有利に働く場合」に用いられているようです。クロコムラサキはコムラサキの暗色タイプで,特定の地域以外では稀にしか観察されていません。私は昆虫採集少年でしたので,未だに虫には興味があります。私の経験では,クロコムラサキには出会ったことがありません。メスグロヒョウモンの雌にも2回程度しか出会っていません。特定の地域以外では,捕食者も同様な体験の持ち主でしょう。ですから,メスグロヒョウモンの雌とクロコムラサキの雌との類似性が適応的な意味をもつ場面は非常に限定的であると考えられます。
コフキカラタチゴケは地衣植物でサルオガセの仲間です。サルオガセと言えば札幌農学校の初代教頭ウィリアム・クラーク博士が,学生と一緒に採集した時のエピソードが有名です。聞くところによると,木から垂れ下がっているサルオガセ(ヨコワサルオガセ)を見つけた彼は,自らが踏み台になって学生にサルオガセを採ってもらったそうです。彼の人柄を推察するものとして語られているようです。ネットで検索すると,彼が採集したヨコワサルオガセは北海道だけではなく,日本全土に分布していたものらしいです。しかし,残念ながら福岡県では絶滅危惧Ⅰ類のようです。
ここで紹介する理由は,サルオガセの仲間で素人でも同定が比較的可能だと思ったからです。特徴は,不規則に分枝して髪の毛のように垂れ下がった本体(地衣体)の枝分かれしている周辺にソラリアと呼ばれるぶちぶち(粉芽)の塊があるそうです。写真を拡大するとぶちぶち(粉芽)が確認できます。
<11月8日>柳川市大和町大坪
今回の話題は「カバマダラ」という蝶です。
今年,台風は上陸しませんでしたが,接近した台風の影響などにより各地で迷蝶が採集されているようです。迷蝶とは,本来棲息していない蝶が台風などの風にのって飛来したものです。場合によっては,しばらくの期間その場所で繁殖することもあります。カバマダラは南の方の蝶で,近年分布が北上していて,現在は九州の南部まで棲息地を広げているようです。ツマグロヒョウモンとの擬態で話題になる蝶で別のページの「ツマグロヒョウモンの擬態と蛹の色」でも取りあげています。私は,ツマグロヒョウモンの♀とカバマダラを同じ場所で確認したのは,福岡県では初めてです。
観察されたカバマダラは写真撮影した個体を含め比較的翅が新しいことから,飛来した個体が繁殖に成功したものと考えられます。食草はキョウチクトウ科のトウワタやフウセントウワタとされていますが,同じ科のガガイモも食べると言われています。周辺にはガガイモはありました。フウセントウワタもあちこちで栽培されているのを見かけます。
現在,南方の蝶が次第に北へ分布域を広げていることが話題になっています。学生の頃宮崎県で見かけたタテハモドキは,もう福岡県に定着しているようで,今秋は自宅の庭でも秋型を確認しました。カバマダラはどうなるでしょうか。個人的には,カバマダラの北上は点から始まり,やがて面へと拡大していくと考えています。問題は,今回の観察が,初期の点として面への発展する点なのか,それとも,直ぐに消えてしまう点なのかです。大多数の点は後者だと言われています。来春気力があれば,越冬しているかどうかを確認してみます。
なお,同じ地点でルリウラナミシジミ♀も確認されましたので写真を載せます。
2021年
-
ハカタシダ
綺麗な斑入りの個体は,園芸にも利用されているそうですが,野外では斑が入らない方が多いとのことでした。
(八女市,2021年4月11日) -
アケビ雄花
小葉が5枚あるのが特徴です。花びらのように見えるのはがくです。
(八女市,2021年4月11日) -
シマサルナシ
実は3㎝位までなるそうです。
(みやま市,2021年10月10日) -
オオハナワラビ
奥に見えるのが胞子葉です。
(みやま市,2021年10月10日) -
スミレモ
オレンジ色に見えるふさふさした部分です。
(みやま市,2021年10月10日) -
アオダイショウ
冬眠前のアオダイショウがとぐろをまいていました。
(八女郡広川町,2021年11月21日) -
モズ(♂)
高鳴きを終了してさえずりをしているところ。
(八女郡広川町,2021年11月21日) -
シロバナタンポポ
筑後では,春の花が一部秋の終わりから初冬にかけて咲いていることがよくあります。
(八女郡広川町,2021年11月21日)
<4月11日>八女市矢部村所野周辺
今回の話題は「ハカタシダ」・「アケビの仲間」です。
シダ植物はどれも同じにみえることは私も多々ありますが,「ハカタシダ」は比較的容易に同定できそうなので紹介します。シダ植物では,地上部に伸びた部分は一枚の「葉」とされています。地面から伸びている茎のような部分は中軸と呼ばれ,羽片と呼ばれる葉状の構造が左右にでています。「ハカタシダ」は左右に長く伸びた羽片の数が少ないのが特徴です。写真のように,中軸や羽片の両側に縦に斑が入ることが野外でも観察されます。斑の入り方が博多帯を連想されるので「ハカタシダ」という和名が付けられたそうです。
今回観察した植物の中で,アケビの仲間に対する私の理解が少し深まりました。歩いていると民家の外庭にムベが咲いていました。会員の方が「ムベは雌雄異花で,雌花が少ないですよ。・・・それ雌花ですね。・・・」と説明されました。雌花です・・・・と言われて見てみると,花の中央部に柱状の構造物が4つ確認できました。アケビの仲間の雌花にはめしべ群と呼ばれているものがあることを事前に学習していませんでしたので,「え?これがめしべ?」という感じがしました。帰宅して調べてみると,何とアケビの仲間は,雌花にめしべが複数あることがわかりました。複数のめしべで思い出されるのが,ABCモデルで有名なシロイヌナズナの変異体です。シロイヌナズナの変異体との大きな違いは,アケビの仲間では通常の野生株の雌花で複数のめしべ(めしべ群)が存在していることです。アケビの仲間は,ABCモデルを別の視点で考えるモデルになるのではないかと考えました。
※5月~9月の例会は中止になりました。
<10月10日>みやま市瀬高町本吉清水寺参道
今回の話題は「シマサルナシ」・「オオハナワラビ」・「スミレモ」です。
「シマサルナシ」は漢字表記では「島猿梨」となります。猿だけでなく,同じ霊長類のヒトが食べても美味しいそうで,「ミニキウイ」という名前で売られているようです。現地では,キウイフルーツの原種という説明でした。調べてみると,「シマサルナシ」とキウイフルーツとは同じマタタビの仲間で,キウイフルーツは中国原産のものが品種改良されたものだとありました。「シマサルナシ」を,キウイフルーツを育てる台木として使用するという記載もあります。確かに,商品価値は今のところキウイフルーツの方が上だとは思いますが,微量成分はどうなんでしょうか。1ヶ月後(11月)には熟して,実は生で食べられると記載されていますので,高枝切りをもっていけば実が採取できるとは思いますが・・・
「オオハナワラビ」は,林床に生育するシダ植物で,胞子をつける胞子葉と,胞子を作らない普通の葉(栄養葉)との2つの異なる形態と機能の異なる「葉」をもっています。地下から立ち上がってくる構造は「葉」であるとされ,茎のように見える部分は葉柄です。「オオハナワラビ」の胞子葉は,葉柄から分岐して形成されていることになります。このような説明は,私たちの直感とはずれますが,ここで注目してほしいことは,種子植物の花との共通性です。多くの種子植物の花は,茎の一部から分岐して形成されます。分化という視点で捉えると,種子植物の花は,茎の一部の細胞が分化して「花」と呼ばれる生殖器官を形成し,その一部が生殖細胞へ分化していくことになります。同じ視点で捉えると,「オオハナワラビ」では葉柄の一部の細胞が分化して「胞子葉」と呼ばれる生殖器官を形成し,その一部が生殖細胞へ分化していくことになります。どうですか?似ていませんか。私には,種子植物の生殖器官への分化を進める遺伝子群とシダ植物の胞子葉形成に関係する遺伝子群とは何らかの関係がありそうに感じられますが・・・。
「スミレモ」は緑藻に分類されています。そう言われて写真を確認すると,確かに緑色の部分もあります。広島大学デジタル自然史博物館のスミレモの記載には,「スミレモという名前は,スミレの香りがするためとの記載が多いが,スミレの香りはせず,英名のRock violet algaeの直訳ではないか。」という趣旨の記載がありました。この意見を読んで写真を見直すと確かに紫色の部分もあります。何らかの条件が整えば,全体が紫色になることも考えられそうですね。
今回話題にしたいのは,バックに写り込んでいる地衣植物との関係です。会員の方の説明によると,「この地衣植物はレプラゴケの仲間で,中にスミレモを住まわせています。おそらく,スミレモの繁殖が制御できなくなって外に飛び出したのではないかと思います。」という仮説を述べられました。勿論,この仮説が正しいかどうかはわかりませんが,地衣植物(レプラゴケの仲間)と共生する藻類(スミレモ)の位置関係は興味深いと感じました。
地衣植物は,菌類と藻類の共生体です。会員の方は,「菌類が,中に藻類を住まわせて農業を営んでいるようなものです。」と例えられます。これは,菌類を中心に地衣植物を捉える考え方だと思います。逆に,藻類中心に共生を考えることもできるでしょう。すなわち,「藻類は単独でも生育できるが,近くに共生する菌類がある時は条件が整えば共生生活を開始する。」といった考え方です。サンゴの細胞内に共生する褐虫藻は,サンゴの成育条件の変化により外へ放出されるとよく記載されていますが,褐虫藻がサンゴから抜け出しているとも考えられそうですね。このように,共生の関係はどちらを主に考えるかによって見え方が変わるようですが,どちらもありそうなところが面白いと思います。
地衣植物が高校の教科書に堂々と登場するのは,分類や生命の歴史ではなく,生態の遷移分野です。地衣植物は裸地に最初に侵入するパイオニア植物としてコケ植物とともに登場し土壌形成に重要な働きをします。それでは,地衣植物はいつ頃地球に誕生したのでしょうか。ネットで検索すると,「進化の歴史,-時間と空間が織りなす生き物のタペストリー,第39話,生命の陸上への進出(文と写真 長谷川政美)」というものを見つけました。一部を以下に紹介します。
5億年ほど前になると地衣類が陸地に現れる。その頃にはすでにオゾン層が形成されていて,太陽からの紫外線はある程度まで遮断されるようになっていたが,乾燥した陸地は荒涼とした生物の生存には厳しい環境だった。そのような環境に菌類(真菌類)と藻類の共生体である地衣類が開拓者として最初に進出した。
地衣類は現在あまり目立つ生き物ではないが,南極大陸から北極圏,高山,砂漠から熱帯雨林などさまざまな環境に生息する。岩石の上などでも育つが(図39-1),水中では生育しない。地衣類は土壌の形成にも重要な役割を果たしており,最初に陸上に現れた地衣類が,あとで植物が陸上に進出するための条件を整えてくれたように思われる。
長谷川政美さんは進化生物学者ですので,一定の論拠に基づいて述べてあると思います。生物の歴史の大枠は化石の証拠をもとに作られています。現存する陸上植物の最古の化石は,現時点では古生代シルル紀のシダ植物のものです。これより古いコケ植物の化石は見つかっていません。地衣植物の化石も同様だとは思いますが,私は情報をもちません。高校の教科書を調べてみると,「オルドビス紀には原始的なコケ植物が誕生していたと考えられるが,・・・」(数研出版)というのが見つかりました。さすがに,上記の記事のような地衣植物の起源はありませんね。化石が見つかっていないものの起源を推定するのには,よくDNAの塩基配列を比較する方法が用いられています。おそらく地衣植物の出現もDNAの塩基配列の比較による推察でしょう。これらの情報を基に植物の陸上進出を時系列で整理してみると
古生代 カンブリア紀 地衣植物の出現(推測)
オルドビス紀 コケ植物の出現(推測)
シルル紀 シダ植物の出現(化石)
となります。まだ十分には検証されていないかもしれませんが,推論の結果は私たちの感覚になじめると思います。教科書では,植物の進化の歴史は,シルル紀で水中の藻類の時代から陸上のシダ植物の時代へと突然切り替わります。上記の流れの方がより自然です。
カンブリア紀に地衣植物が出現したとすると,当然,それより前に陸上には藻類及び菌類が上陸していたことになります。そして,両者の一部から共同生活に成功した集団が誕生し,より広い範囲に進出していったことが予想されます。カンブリア紀の水中では,多細胞生物の化石が飛躍的に増え,「カンブリア紀の大爆発」と呼ばれています。そして,陸上に目を移すと植物たちの「大上陸」が始まることになります。植物群落の遷移の第一歩と同じ風景が,カンブリア紀に始まり,生命の進化の流れにしたがって,次第に参加者を増やしながら,現在の極相林に到達したとも考えられそうです。もう一度写真を見てみると,岩石の表面に地衣植物と藻類とが共存しています。このような風景は,きっとカンブリア紀の陸地のいたる所にみられた風景かもしれません。
<11月21日>八女郡広川町龍光寺公園付近
今回の話題は「アオダイショウ」・「モズ」・「シロバナタンポポ」です。
幼少の頃,私は「ヘビ三匹ルール」というのを決めていました。ヘビが苦手で,近くの小川にひとりで遊びに行くときは,ヘビに三匹出くわしたら自宅に引き返すことに決めていました。ヘビが正確に三匹だったかは覚えていませんが,多くのヘビに出くわして自宅へ逃げ帰ったことは覚えています。ヘビは身近でしばしば出くわす存在でした。これは,半世紀以上も前の話です。しかし,近年は年々見かける数は減少しているように思われます。写真の「アオダイショウ」も久しぶりに見かけました。冬眠前の個体だと思いますが,みんなで「アオダイショウ」を見て,喜ぶ時代になったということです。ちなみに,動物の種名の「あお」は緑色を指すことが多いようです。
「モズ」は,歳時のコーナーでもとりあげることになった鳥です。「モズ」と言えば高鳴きやはやにえが有名ですが,私は近年自宅周辺では確認したことがありません。久しぶりにモズの高鳴きが聞こえたので,できるだけ近づいてカメラを構えていると高鳴きを止めていました。カメラを構えてじっと待っていると,別の鳴き声が聞こえてきます。モズの喉が動いているようにもみえます。「え?」と思いましたが近くに別の鳥がいる可能性もあります。ひたすら高鳴きを始めるのを待っていましたが,諦めて帰ることにしていると,「モズ」は何処かえ飛んで行ってしまいました。帰って調べてみると「モズ」は「百舌鳥」という表記があり,雄は様々な鳴き声をもっているそうで,雌への求愛に使用されているとのことでした。観察時の率直な感想は,高鳴きって以外と短時間で終わるんだなという感じでした。しかし,実際は観察した雄は,高鳴きと鳴きまねで盛んに雌へアピールしていたということになります。
在来種の「シロバナタンポポ」はこの頃自宅では見かけなくなりました。周辺でも減少しているように思われます。懐かしい気がしたので写真を撮りました。タンポポの仲間の分布の変化はよく種間競争のテーマとして研究されているようですが,関係する要素が複雑すぎてどうもしっくりいくような成果が出ていないような気がします。益村先生の話では,この辺(筑後市)は,昔はタンポポと言えばシロバナ(タンポポ)で,黄色(セイヨウタンポポ)を見つけるとみんなに自慢していたそうです。分布域にもシロバナタンポポの数が減っているらしく,現役時代にはシロバナタンポポを研究している方へシロバナタンポポのたね(果実)を送ったのを記憶しています。近未来にはこの辺(筑後周辺)でも,シロバナタンポポを見つけると自慢できる時代になるかもしれません。
ページ先頭へ
2022年
-
ニワトコ
花は先端部にかたまってつきます。この花が歌の歌詞になるとは,思いませんが・・・。
(八女市,022年4月10日) -
在来種タンポポ1
アスファルト道路の脇に咲いていたものです。けっこうな数があったような気がします。
(八女市,2022年4月10日) -
在来種タンポポ2
花の裏側の様子です。これまで見たことのあるタンポポとはかなり雰囲気が異なります。
(八女市,2022年4月10日) -
フウロケマン
花柄の後側に飛び出した部分(距)が類似種のホザキケマンより長いそうです。
(八女市,2022年4月10日) -
ジャゴケ
葉状体(葉の様にみえる部分)の表面がヘビの鱗に似ているので,蛇苔と呼ばれているそうです。
(八女市,2022年4月10日) -
タマゴケ
玉の用にみえる構造(さく)が丸くなるのが特徴です。
(八女市,2022年4月10日) -
フデリンドウ
草丈があまり大きくならないリンドウです。葉が筆のような形をしています。
(八女市,2022年4月10日) -
フタホシシロエダシャク
前翅に褐色の斑紋があるのが特徴です。
(八女市,2022年4月10日) -
夏緑樹林林の林床
スズタケが枯れた林床の様子です。スズタケ以外に複数の植物が確認できます。
(八女市,2022年5月8日) -
スズタケ
スズタケは葉の表裏に毛がありません。葉の縁が白くぬけていない葉は今年形成されたものです。
(八女市,2022年5月8日) -
シキミ
有毒植物です。花の中心部にめしべが8本あり,八角に似た実をつけます。
(八女市,2022年5月8日) -
ツクシマムシグサ
仏炎苞の内側に柱のよう見えているのが付属体です。この下部に雄花もしくは雌花の集団がつきます。
(八女市,2022年5月8日) -
ヒメバライチゴ
林床部分に多く見られました。小葉はやや小さめで裏側に腺点が多くあります。
(八女市,2022年5月8日)) -
ユキザサ
林床に生え,葉はやや広くササの葉に似ていますかね?花は雪のように白いことからユキザサと呼ばれているそうです。
(八女市,2022年5月8日) -
ヤマルリソウ
日陰に咲いています。葉の縁がひだ状になります。
(八女市,2022年5月8日) -
キンモンガ(白色型)
多くの個体は写真で白く見える部分が黄色になります。
(八女市,2022年5月8日)
<4月10日>八女市星野村石割岳登山道周辺
今回の話題は「ニワトコ」・「フキ」・「タンポポ」の花です。
ニワトコの花が咲いていました。ニワトコと聞いて思い出すのは,学生時代,幹にはえたキクラゲをとって食べたことです。何でも,キクラゲの仲間には有毒な種はないと教えられました。音楽の世界には,「白いリラの花がまた咲くとき」という歌があるそうです。この歌の原曲はドイツで,リラは当時のドイツ語の方言ではニワトコの仲間を指すそうです。ですから,原曲の題は「白いニワトコの花がまた咲くとき」だったという主張になります。この主張がどれだけ正しいのかはわかりませんが,この歌が日本語に翻訳されるときに,リラがスミレに変わったというのは事実のようです。日本では,某歌劇団が歌う「すみれの花が咲く頃」で花が最初はニワトコの花だと思うと,イメージが変わる人も多いのでは・・・。ちなみに,私はリラとライラックが同じ花だと知ったのは,二十歳を随分過ぎてからのことです。外国語は難しいですね。
フキの花を形成する構造がフキノトウです。フキは雌雄異株で雄株と雌株とがあります。写真と簡単な説明は,「参考資料3 フキノトウ」に載せています。ホームページで「花」のページを載せることになりいろいろと調べていると,身の回りには思いの外雌雄異株があることを知り驚きました。その中でもフキはちょっと風変わりな雌雄異株です。雄株も雌株もともに両性花をつけるのです。雄株の両性花は花粉を提供し,雌株の両性花は蜜を提供し,ともに結実しません。結実までこぎ着けるのは,雌株の中に形成される雌花のみです。この春は,大好きなフキノトウを食べずに観察を試みました。自宅で観察されるフキノトウには2種類のパターンがあります。1つは,晩秋から初冬に葉の付け根に形成され,その存在が外からも確認できるものです。そこで,「地上部に形成されるのが雌株で,地下部から新しく現れてくるのが雄株である。」という仮説をもっていましたが,全くのはずれで,自宅で自生しているのは全て雄株で,冠毛は少し形成されましたが,種子はできていませんでした。場所的には少し離れた場所にありますが,元は同じ栄養体に由来しているかもしれません。
雌株は珍しいのでしょうか。今回の観察会の個人的な目標は「フキの雌株を見つけること」でした。星野村は平地より約1ヶ月春が遅れているようで,フキは今が花盛りでした。そして,雄株も雌株もたくさん観察することができました。
帰りにトイレに立ち寄った小さな公園に「在来種タンポポ」と思われるものが咲いていました。タンポポの花の話をすると,必ず総包外片を確認するという話になります。「Ⅼ10-8 タンポポを調べてみよう」で紹介したカンサイタンポポは「タンポポ調査・2010西日本」で「カンサイタンポポ」として登録されたタンポポと同じ場所で開花したものです。表現は回りくどいですが,「カンサイタンポポ」として掲載しても大丈夫だろうと思うものです。あらためて写真の在来種タンポポを見てみましょう。在来種としての特徴は十分満たしていますが,明らかにカンサイタンポポとは異なるようです。ネットの検索で,以下の資料を見つけました。これらの記載を参考にすると,「オキタンポポ」が最も類似しているようです。星野村は八女市の奥にあり,八女市との合併であえて以前からの地名を残したという場所です。在来種が生き残っていても不思議ではありません。そこで問題は,「公園の土とともに他の地域から侵入した。」のか,それとも,「昔から繁殖していたものが公園にも侵入した。」のかです。私の感覚では,前者の可能性が高い気がしました。道路脇に咲いているタンポポを眺めながら帰宅しましたが,どうも似たようなタンポポがたくさん咲いていた気がしました。誰かタンポポに興味がある人がいたら,調べてみると面白いのではないかと思います。
<参考資料>
タンポポ・・・福岡教育大の先生のサイトです。
https://staff.fukuoka-edu.ac.jp/fukuhara/keitai_low/tanpopo.html
オキタンポポ(隠岐の島)・・・やや学術的な内容です。(セキュリティなしとあります。)
http://taraxacum.sakura.ne.jp/oki.html
<5月8日>八女市矢部村釈迦岳登山道周辺
今回の話題は「スズタケ」・「シキミ」・「ツクシマムシグサ」です。
2021年竹の開花が各地で話題になりました。竹は花を一斉につけて枯れるという性質があるとされています。「スズタケ」・「一斉開花」で検索すると,複数年・複数地点での例が出ています。「120年に一度」という言葉が飛び交っています。この数字に関して良心的なサイトでは詳しい研究はないとしています。どの程度の頻度でタケやササに花が咲いているという明確な研究はないというのを私も支持しています。私はモウソウチクの花をみたという明確な記憶はありませんが,ササ類は複数回見たことがあります。
写真の夏緑樹林(ブナを含む)の林床では,スズタケが一斉に枯れているのが確認できます。おそらく2021年に一斉開花が起こっていたのではないかと推測します。スズタケの写真には,葉の縁が白くなっているものとそうでないものが確認できます。葉の縁が白いのは,冬越しの葉です。寒い冬に葉の凍結を防ぐため,葉の中央部の細胞の浸透圧を上昇させるそうで,その分の物質を葉の縁の細胞から調達し,結果として葉の縁の細胞が枯死して白い縁取りができるそうです。この写真から,前年の一斉開花ではすべて枯死した訳でもなさそうな気がしています。
長年この地域のブナ林を研究されていた宝理信也先生は,「この様に林床をスズタケが覆っていますと,ブナの芽生えが育たなくなるので,ブナ林の維持が難しくなります。」と心配されていました。ブナ林の維持には,スズタケの一斉開花は明るい要素になると思います。要はスズタケの一斉開花の起こる頻度ということになりそうです。
シキミの花が咲いていました。会員の方の説明では,「仏壇にあげるのは正式にはシキミで,神棚にはサカキです。」とのことでした。「え?」と思い,帰ってネットで調べてみました。私は仏壇にシキミなどあげた経験はありません。ネットでは仏教の多くの宗派でシキミが仏事に用いられているとあります。その起源として,「鑑真が唐から持ち込んだという言い伝え」や「空海が修行で樒を使ったという説」などが紹介されています。
ここで,いつも参考にさせてもらっている「三河の植物観察」の記載の一部を引用します。
シキミ 樒
別 名 ハナノキ、ハナシバ
中国名 日本莽草 ri ben mang cao 日本八角 ri ben ba jiao
在来種
トウシキミ 唐樒
中国原産。中国名は八角 ba jiao。果実はスターアニス、八角、大茴香(だいういきょう)などと呼ばれる中華料理の香辛料。
これらの記載から,もし,鑑真が唐からシキミの仲間を持ち帰ったとしたら,それはトウシキミだったことになります。トウシキミの実(八角)は香料として料理に使用されていますが,シキミは有毒です。なぜ,この有毒植物が日本の仏教の多くの宗派で使われているのかは不思議です。今度寺に行ったら,シキミが使用されているかどうか確認してみたいと思います。それにしても,シキミの中国名が「日本莽草」と呼ばれているのは面白いと思いました。
マムシグサの仲間は面白い花の形をしていますが,変異が大きくどこまでが同じ種に属するのか簡単に判別が難しいようです。「ツクシマムシグサ」は他種と区別がつくので,この機会に紹介します。仏炎苞(ぶつえんほう;外側にある屋根のように覆い被さり,花びらのように見える部分)の先端部が尾状に長く伸びるのが特徴です。林道を登っていると「やっと,ツクシマムシグサがあった。」と会長が教えてくれました。ネットでも詳しい分布は説明されていませんでしたが,やや高度の高い場所にあるようです。帰り道で,どの辺までツクシマムシグサがあるだろうかと確認しながら歩きましたが,下るにつれて次第に減少しているようでした。
マムシグサの仲間は「雌雄偽異株」という不思議な性質をもっています。ツクシマムシグサも「雌雄偽異株」と記載されていました。「雌雄偽異株」とは,栄養体の栄養状態により,雌花もしくは雄花のみを形成する株です。マムシグサの仲間では,貯蔵物質の少ない若い株は雄花を形成し,貯蔵物質が十分になると雌花を形成します。咲いている花の性は1つですが,同じ株が雄株から雌株へと性転換をしていくことになります。マムシグサの仲間の個体は,雄株から雌株へと変化していきますので,雌雄異株に特別に「偽」という字が入るようです。
ページ先頭へ
-
マルバツユクサ
ツノクサよりも葉が丸くなります。
(筑後市,2022年6月12日) -
マルバツユクサの地中花
丸く膨らんでいる部分が地中花です。底側の袋(苞)の中に果実が形成されます。
(筑後市,2022年6月12日) -
ウマノスズクサ(雌性期)
花の裏側に長い毛がたくさんあるのがわかります。
(筑後市,2022年6月12日) -
ウマノスズクサ(雄性期)
花の内側の毛はすっかりめだたなくなり,奥への通路がはっきり確認できます。
(筑後市,2022年6月12日) -
ジャコウアゲハの幼虫1
幼虫の食草はウマノスズクサです。ジャコウアゲハの幼虫は最後まで緑系の色にはなりません。
(筑後市,2022年6月12日) -
ジャコウアゲハの幼虫2
オレンジ色に見える部分は臭角(匂いを出すところ)です。臭角は他のアゲハの仲間のように長くは伸びません。
-
ジャコウアゲハの蛹1
ジャコウアゲハの蛹は最初は薄い褐色ですが,やがて色が濃くなります。
(筑後市,2022年6月12日) -
ジャコウアゲハの蛹2
ジャコウアゲハの蛹は「お菊虫」とも呼ばれているようです。不気味な姿は妖怪を連想しそうですね。
(筑後市,2022年6月12日) -
ジャコウアゲハ(♀)
ジャコウアゲハやオナガアゲハは他のアゲハの仲間よりも後翅が細長いです。ジャコウアゲハの雌は雄よりも翅の色は茶色ぽくなります。
(筑後市,2022年6月12日) -
キバナニワゼキショウ
黄色の花をつけるニワゼキショウです。2年前の観察会では発見されていませんでした。
(筑後市,2022年6月12日)
<6月12日>筑後市津島広域公園
今回の話題は「マルバツユクサ」・「ウマノスズクサ」・「ジャコウアゲハ」です。
「マルバツユクサ」は,外来種と思い込んでいましたが,在来種との記載もあります。分布は広く,海岸部に多いとの記述が多いようですが,近年都市部でも普通に観察されるようになっていると思います。今回紹介するのは,地中花です。地中に花を咲かせるイメージとはやや異なります。「閉鎖花」と呼ばれる開花することのない花です。「閉鎖花」は自家受精で種子を形成するとされていますが,どのような過程で地下部の「閉鎖花」が自家受精するのかは,なかなかイメージが湧きませんね。地上で観察される閉鎖花には,スミレの仲間があります。6月にスミレの仲間の根元付近を観察すると,ドラゴンのような形をした花芽があります。スミレの仲間が秋に種子を飛ばしているのは,春に受粉したものではなく,閉鎖花が結実したものです。海岸部では,潮風などの影響で地上部がダメージを受けることもあるでしょう。地上部が塩害で枯死しても,地下部に種子があれば安心でしょう。都市部でもヒトが行う刈り取りなどのダメージを軽減できそうな気がします。ヒトの立場からは厄介な雑草ということになります。
「ウマノスズクサ」は,花の形から鈴をイメージしたことによる命名です。ウマに付ける鈴の方がウシに付ける鈴よりも小さいのですかね。ジャコウアゲハの食草として知られています。公園内をジャコウアゲハが多数飛んでいるので,「何処かにウマノスズクサがないかな。」と探していたら,隣接する矢部川の河川敷に多数あることがわかりました。探索を続けていると開花しているものが見つかりました。自宅で写真を整理していると,雰囲気がことなる写真がありました。花の奥に多数の毛が確認できるものとそうでないものです。いつも参考にさせてもらっている「三河の植物観察」の「ウマノスズクサ」を開いてみると,「雌性先熟で,雌性期には筒部の逆毛が長く,ハエが入ると出られなくなる。雄性期には逆毛が萎縮してハエが出られるようになる。」との記述がありました。なる程と思いましたが,「最初に開花した花は自家受精?」,「蜜はいつ頃まで分泌されるのですかね。」などという素朴な疑問が新たに生まれました。
「ジャコウアゲハ」の名称は,成虫の雄が分泌する雌を誘引する物質(フェニルアセトアルデヒド)が,ジャコウジカ(麝香鹿)の雄が分泌する麝香に似ていることに由来します。ともに性フェロモンとして働いているようです。幼虫はウマノスズクサを食べ,その毒素(アリストロキア酸)を体内に蓄積することで身を守ります。この毒は成虫ももっていて一度成虫を捕食した鳥は中毒を起こし吐き出し,二度と食べないと言われています。ウィキペデアによると,ジャコウアゲハに似た形態をもつもの(ベーツ擬態)の例として,「クロアゲハ」・「オナガアゲハ」・「アゲハモドキ」があがっていました。これらの種類がどれ程似ているかの判断は鳥さんに任せるしかありませんが,結構有効に擬態が働いているような気がします。
ページ先頭へ
-
ヒメオサムシ
飛べない昆虫として,多くの変異が見つかります。このグルーブの分類は細分化されて素人には難解過ぎます。
(八女市,2022年7月10日) -
フクラスズメの幼虫
下が頭部で,左右に動かして威嚇している所です。
(八女市,2022年7月10日) -
エダナナフシ♂
前方に前脚を伸ばしています。お尻の膨れているのが雄です。
(八女市,2022年7月10日) -
シロカネグモの仲間
コシロカネグモではないかと思いますが,腹部がパール色をしています。
(八女市,2022年7月10日) -
アミメオオエダシャク
模様が鮮やかなシャクトリガですが,食草などの情報は見つかりませんでした。
(八女市,2022年7月10日) -
ギンモンシロウワバ1
模様が面白いと思いました。この翅の模様は様々な変異があるようです。
(八女市,2022年7月10日) -
ギンモンシロウワバ2
幼虫はヨモギの仲間を食べているようです。
(八女市,2022年7月10日) -
トラフシジミ終齢幼虫
幼虫はフジを食べると思っていましたが,比較的多くの植物を食べているようです。
(八女市,2022年7月10日) -
キタキチョウ
以前は「キチョウ」と呼ばれていましたが,南西諸島にのみ分布しているものとは,別種であるとされました。
(八女市,2022年7月10日) -
ミヤマカワトンボ
後翅の際の方にやや濃い部分があります。
(八女市,2022年7月10日) -
ムネアカオオアリ
山でよく見る大型のありです。周りにいるアブラムシとの関係は不明です。
(八女市,2022年7月10日) -
ネムノキ
花弁はほとんど目立たず,ピンクに見えるのはおしべです。
(八女市,2022年7月10日)
<7月10日>八女市矢部村北矢部
今回の話題は「ヒメオサムシ」・「カラムシとフクラスズメの幼虫」・「ナナフシの仲間」です。
「ヒメオサムシ」はオサムシと呼ばれる飛べない昆虫の仲間です。漫画家の大先輩の手塚治虫のペンネームは,少年時代昆虫が大好きだったことからと言われています。本名は「治」で,一時期は「治虫」は「オサムシ」と読ませていたそうです。「オサムシ」は昆虫マニアの中では人気のグループです。私も高校時代に友人と採集に出かけていました。地域による変異が多く,特に,前翅の光沢には独特の魅力を感じていました。進化の研究にもよく利用されていて,興味深い研究もされているようです。
子供の頃は,「カラムシ」と言えば,ラミーカミキリでした。しかし,得体の知れない蛾の幼虫が大量に発生しているのをよく見かけていました。いつも,その数の多さに圧倒されていた気がします。これが,「フクラスズメ」の幼虫です。刺激をすると,頭部を振って威嚇してきます。いかにも,毒がありそうな毛虫ですが,無毒とのことです。
「ナナフシの仲間」は7つの体節をもっている訳ではありません。なぜ「七」なのかはわかりませんが,多くの節が目立つからだろうということになりました。現場の説明では,「ナナフシモドキ」という言葉が飛び出しました。帰って調べてみると,「ナナフシ」は,ナナフシモドキ科に属していて,別名を「ナナフシモドキ」と呼んでいるようです。写真は「エダナナフシ」で,何とトビナナフシ科に属しています。これが,飛ぶとは考えられないので「なぜ?」と思っていると,トビナナフシ科に「エダナナフシ亜科」と「トビナナフシ亜科」とがあったので,ここで納得することにしました。「ナナフシ(ナナフシモドキ)」と「エダナナフシ」とはよく似ていますが,触角の長さが前足の長さに比べて明らかに短い方が「ナナフシ(ナナフシモドキ)」です。
今回は多くの昆虫に出会いましたので,それも加えて掲載しました。
ページ先頭へ
-
ツユクサ(めしべあり)
おしべが奥から3本,1本,2本あるのがわかります。
(八女市,2022年8月21日) -
ツユクサ(めしべ(なし)
前方のおじべのやくから花粉がこぼれるように出ているのがわかります。
(八女市,2022年8月21日) -
ペラペラヨメナ
中央アメリカ原産。栽培されいたものが逸出し野生化したもの。
(八女市,2022年8月21日) -
ノリウツギ
ウツギのように白い花を咲かせ,樹皮から和紙ののりを作るための成分がとれることから,命名されたそうです。
(八女市,2022年8月21日) -
イヌカタヒバ
古びた神社の中にたくさん生えていました。先端部に生殖芽ができ始めています。
(八女市,2022年8月21日) -
イヌワラビ
教科書でおなじみのシダです。変異が多く何となく同定が難しい気がします。
(八女市,2022年8月21日) -
スミレホコリタケ
成熟すると中にスミレ色の胞子ができます。
(八女市,2022年8月21日) -
ウメノキゴケ
梅の木以外でも観察されるようです。類似した種があり同定は難しいようです。
(八女市,2022年8月21日) -
ヒメキマダラセセリ?
右に前翅,左に後翅の模様が見えています。
(八女市,2022年8月21日) -
ハンミョウ
ミチオシエともいい,独特の金属光沢が特徴です。
(筑後市,2022年8月21日) -
オナガサナエ(♂)
尾部付属器(お尻の先の構造物)が長いのが特徴です。
(筑後市,2022年8月21日)
<8月21日>八女市黒木町大渕周辺
今回の話題は「ツユクサ」・「イヌカタヒバ」です。
「ツユクサ」は夏の風物詩ですが,生物学的には,めしべがある花とない花をつけると言うことが有名です。「ツユクサ」について調べてみると,おしべは6本で,奥の3本及び中間の1本は仮おしべと呼ばれ,「三河の植物観察」によれば,3本は花粉が少し出るが不稔,中間の1本は花粉の量が少ないと記載されていました。他の資料には,これらのおしべは花粉がないという記載もあります。色的には,めだつ4本のおしべははたしてどんな役割があるのでしょうか。めしべがある花は,他家受精が成立しないときは,めしべが収縮して一番長いおしべと自家受精が成立します。では,めしべをもたない花はどうでしょう。もし,昆虫などのポリネーター(送粉者)が来なければ,子孫を残すことにかかわることができません。ツユクサでは蜜はでないとの記載もありますので,ポリネーターを呼ぶには,花粉が重要な意味をもっていると思われます。めしべをつくるコストを省略して,花粉製造に専念する花にはそれなりの合理性があるような気がします。有性生殖に深いこだわりがあるわけでもないかもしれません。
「イヌカタヒバ」は元々八重山諸島のみに分布していたものが,植木栽培などにもちいられ,それが逸出して全国に広がったそうです。本家の石垣島では絶滅危惧種だそうですが,筑後では普通に見られます。国内帰化植物という言い方をするようですが,本当にそれだけでしょうか。地球温暖化の影響を指摘する声もあるようです。シダ植物ですから,胞子はそれなりの距離,風で運ばれることが想定できます。どのような場所で「イヌカタヒバ」が見つかるかを吟味すると,答えは逸出だけではなかったということもありえるのではないかと思います。「カタヒバ」とは,葉には鋸歯があり表面につやがなく,先端部に生殖芽を作ることで区別できそうです。
ページ先頭へ
-
キンモンガ(白色型)2
春と秋に発生するようです。翅を広げて,盛んに花の上を動きまわります。
(かんかけ峠,2022年9月11日) -
コミスジ
羽化に失敗しているので何となくグロテスクにみえますが,翅を広げてとまることの多いチョウです。
(かんかけ峠,2022年9月11日) -
イヌタデ(白花)
(かんかけ峠,2022年9月11日)
-
イヌタデ(白花と赤花)
林縁で白花と赤花が観察できる場所がありました。
(かんかけ峠,2022年9月11日) -
カナムグラ(雄株)
その名の通り茎や葉の表面がザラザラしています。雌雄異株
(かんかけ峠,2022年9月11日) -
ゲンノショウコ
白色花もあり,その割合は地域によって異なるそうです。
(かんかけ峠,2022年9月11日) -
キツネノマゴ(白花)
道端などで普通に見られますが,比較的多くの白花があります。
(かんかけ峠,2022年9月11日) -
メリケンムグラ
北米原産の外来種で,川縁や田んぼの畦などでよく見られますが,なぜか山の上にありました。
(かんかけ峠,2022年9月11日) -
ヤマホトトギス
めしべの花柱の基部にもようがあり,花被片(花びら)は反り返ることが多いそうです。
(かんかけ峠,2022年9月11日) -
コバノボタンズル
名前と姿形がよく似たコボタンズルは九州にはないようです。
(かんかけ峠,2022年9月11日) -
オトギリソウ
薬草として用いられていたようです。葉や花に病気ではないかと思わせる黒点があります。
(かんかけ峠,2022年9月11日)
<9月11日>かんかけ峠(久留米市田主丸町と八女市上陽町の間の峠)
今回の話題は「チョウとガの違い」・「タデの同定について」です。
今回の観察会では,今年5月に紹介したキンモンガが何回も現れました。キンモンガは昼行性のガで花にも来るようです。そこで,話題になったのが,「チョウとガの違い」です。会員のひとりが,「チョウは・・・,ガは・・・・。しかし,結局,決定的な違いはないので,そのグループ(分類郡)を総合的に判断して,ガかチョウかを判断してどちらかに入れています。・・・」という主旨の説明をされていました。要するにチョウとかガというのは系統的な分類の単位ではないということです。チョウとガを区別する単語が存在しない言語も多数あるようです。今回はコミスジというチョウを比較のために掲載しました。コミスジは多くのガの仲間のように翅を広げたまま止まっていることが多いようです。写真の個体は残念ながら,羽化で何らかのトラブルがあったようで,後翅は十分に伸びきれなかったようです。
今回話題になったのが,写真の白いタデ科植物です。私は,タデ科は苦手なので,皆さんの話を聞いていると,「このようなタデは見たことがない・・・」などと,新発見(確認)ではないかという主旨の発言もありました。しばらく進むと,今度は赤い花と白い花とが混在して咲いている場所が見つかりました。赤い花を観るとどうも「イヌタデ」のように見えます。議論でも,ともに「イヌタデ」であるという決論になりました。勿論,議論で同定する訳ではありません。具体的な形質を比較する必要があります。何が議論されていたかは明確な記憶がありませんので,珍しくサンプルを持ち帰り自宅でも調べてみました。葉の基部にある托葉鞘(茎を筒状に包み込んでいる部分)にある毛が長いのが「イヌタデ」と「ハナタデ」です。典型的な図や図鑑形式の写真とサンプルとを比較すると,「イヌタデ」は花がもっと密に,「ハナタデ」はもっとまばらに付くようです。なお,写真のみのネット情報では,判断ができませんね。そこで,いつもお世話になっている「三河の植物観察」の記載を参考にすると,「ハナタデ」は「小花柄がイヌタデより長い。」という点で,「イヌタデ」という決論を支持することにしました。気になる記載としては,「ハナタデ」の冒頭にある記載で「葉がイヌタデと似ているが日陰にも生え,別名はヤブタデと呼ばれ,林縁で普通にみられる。イヌタデと同じような場所に生えるものは花もイヌタデに似ている。」という点です。今回観察された「イヌタデ」と同定した植物は,林縁で多く見られました。そこでかってな想像ですが,「ハナタデ(ヤブタデ)のように日陰にはえているイヌタデは,ハナタデに似る。」こともあるのではないかと思いました。植物の同定は本当に変異が多くて大変だなと思います。
ページ先頭へ
-
フタモンアシナガバチ雄1
腹部に黄色い紋が2つあるのが特徴です。雄の上に,雄がかぶさり交尾のまねごとをしています。
(大木町,2022年10月16日) -
フタモンアシナガバチ雄2
2頭の雄の所へ別の雄がやって来ているところです。このような場面は,通常の交尾でも見られます。
(大木町,2022年10月16日) -
ヒメアカタテハ
アカタテハと異なり,後翅が橙色で3列の黒班にがあります。世界中に分布しているそうです。
(大木町,2022年10月16日) -
オオイヌタデ
典型的なオオイヌタデです。葉の側脈の数が多いのが写真でも確認できます。
(大木町,2022年10月16日) -
ホシアサガオ
中心部が濃い紅色で,その周りが明るい色になっています。星が輝いているようにみえますか?
(大木町,2022年10月16日) -
マメアサガオ
花は淡紅色のものもあるそうです。葯は紫色をしています。
(大木町,2022年10月16日) -
カルガモの番?
(3列風切?)羽の縁の白が大きい方(左)が雄です。数羽で群れていました。
(大木町,2022年10月16日) -
野生化した家禽?
カルガモの群れの中に混じって行動していました。血縁があるかどうかは不明です。
(大木町,2022年10月16日)
<10月16日>三潴郡大木町道の駅おおき付近
今回の話題は「フタモンアシナガバチ」・「タデの同定について」です。
道中いたる所に「フタモンアシナガバチ」が群れていました。どうせ雄だろうと思い,近づいて写真をとりました。ハチの毒針は産卵管が変化したものなので,当然雄にはありません。観察していると盛んに集まってくる感じです。何をしているのだろうとネットで検索すると,誤認交尾らしいです。誤認交尾とは,あぶれ雄が他の雄に交尾のまねごとをする行為です。雌雄の違いを検索すると,雄は顔面(頭楯)が黄色い仮面のようになること,触角の先端がカールするように丸くなることが記載されていました。残念ながら,顔を正面から撮影したものはありませんでしたが,触角の形状から全て雄であることが判明しました。秋のもの悲しい風景です。
タデ科の種名をどのようして覚えていくかという問題に明快な答えはないでしょう。折に触れ,ボチボチ覚えていくしかなさそうです。今回,写真で紹介するのは,「オオイヌタデ」です。三河の植物観察を引用すれば,「オオイヌタデ」は「茎の節のふくらみが大きく,花序が長く,先が垂れ下がる。葉の側脈が20~30対。」となっています。これに対して,「類似のサナエタデは茎の節の膨らみが少なく,花序が短く,先がほとんど垂れない。葉の側脈が7~15対と少ない。」と記載されています。初めて知ることは,「サクラタデ」は「オオイヌタデ」の変種として扱われることもあるそうです。このような話を聞くと,タデは益々厄介な存在になりそうです。長田先生の野草図鑑では,両者の中間型もあるとのことでした。素人としては,深入りしないほうが良さそうですね。
ページ先頭へ
-
スイカズラ
別名金銀花ともいうそうです。問題は,白から黄色に変化するまでの時間と,おしべのやくから花粉放出の変化ですかね。
(八女市,2022年11月20日) -
ユキノシタの紅葉
葉が1枚だけ紅葉していました。自宅のユキノシタではまだ観察例がありません。
(八女市,2022年11月20日) -
ビワ
晩秋から年明けにかけて開花するようです。
(八女市,2022年11月20日) -
ニッケイ
九州にはニッケイの自然分布はないとされているそうです。
(八女市,2022年11月20日) -
フユノカナワラビ
夏には枯れ,冬は緑になる冬緑性です。
(八女市,2022年11月20日) -
サワガニ
渓流周辺でよく見かける淡水性のカニです。
(八女市,2022年11月20日)
<11月20日>八女市立花町神辺春松尾弁財天付近
今回の話題は「スイカズラの花の色」・「ユキノシタの紅葉」です。
「スイカズラの花の色」は開花した時は白色で,次第に黄色く変わっていきます。写真のように白い花と黄色い花とが並んで咲いているのは,よく見かける光景です。これは,開花日の異なる花が並んでいるわけです。では,なぜ花の色が変わるのでしょうか。耳学問では,受精が成立すると花の色が変わり,送粉者に知らせるとのことでした。ネットで検索すると,「受精が成立しなくても花の色は変化する。」という記事がありました。この記事だけ参考にすると,花色の変化と受精は無関係のようにも思われます。別の記事では,白色の花が花粉を放出している写真と,黄色い花で花粉放出を終了してやくが枯れている状態の写真とが掲載され,花の色がむしたちに花粉の有無を知らせるサインになっているとの説明がありました。この説明だと,受精が成立しなくとも花の色が変化しても不思議ではないことになります。「花粉形成」と「受粉」とは全く独立した事象ではありませんので,花の色の変化が送粉者に花粉を別の花に運んでもらい,受精の効率を上げる効果がありそうな気がします。今度スイカズラの花を観察するときは,花粉放出の有無にも注意をはらって見ることにします。
ユキノシタの葉が1枚だけ紅葉していたので写真を撮りました。ネットで検索してみると,紅葉している写真はありましたが,その紅葉の仕組みを説明している記事は見つけることができませんでした。ユキノシタの葉は原形質分離の実験でよく用いられています。裏面の表皮細胞にたくさんのアントシアンを含む細胞が多く,うすい赤色をしていて細胞壁とその内側の形状が顕微鏡でも観察しやすいです。表面もやや赤みを帯びているものもあります。ですから写真の赤い葉は,細胞内の葉緑体が退行したということでしょう。しかし,葉緑体が完全に消滅したのか,それとも,色素だけが分解され再び緑の葉が復活するのかは,継続観察をしてみないとわかりません。
R3 日生教2019年岡山大会から
-
オオサンショウウオ
はんざきセンターで飼育されている個体。
(岡山県真庭市,2019年8月7日) -
地衣植物(キゴケ?)の仲間
蒜山塩釜養魚センターの庭石の上に生えていました。
(岡山県真庭市,2019年8月7日) -
水源からの流れだし
塩釜の冷泉からの流れだしです。
(岡山県真庭市,2019年8月7日) -
バイカモの仲間
(岡山県真庭市,2019年8月7日)
-
珪藻土の露天掘り
露天掘りの様子です。
(岡山県真庭市,2019年8月7日) -
珪藻土
平行に並んでいるのが珪藻土の堆積した層です。
(岡山県真庭市,2019年8月7日) -
採掘地内の水路
水路が褐色に見えるのは微生物の繁殖によるものです。
(岡山県真庭市,2019年8月7日) -
蜂球(セイヨウミツバチ)
ミツバチの隙間からスズメバチの頭部が覗いています。
(岡山県苫田(とまた)郡,2019年8月8日) -
女王バチと働きバチ
中央やや下の腹部の長い個体が女王バチです。
(岡山県苫田(とまた)郡,2019年8月8日) -
バイオハザードのマーク
岡山県農林水産総合センター生物科学研究所
(岡山県加賀郡,2019年8月8日) -
遺伝子組換え実験
Aは大腸菌にGFP遺伝子を導入したもの。
(岡山県加賀郡,2019年8月8日) -
遺伝子組換えのタバコ(A or B)
どちらが遺伝子組換えのものかは忘れました。
(岡山県加賀郡,2019年8月8日)
日生教というのは,生物の教育に関係している人たちによる全国研修組織です。年1回夏にどこかの県で全国大会を開催しています。この夏の大会は,岡山県で開催されました。講演や研究発表などもあるのですが,何といっても目玉は現地研修です。今回は,研究発表1本と自身が参加した現地研修の報告をします。
今回の1本は,千葉県立浦安南高の先生の「ポケットで育てるMyクラゲPart2」です。なんでもポケットサイズの容器の中で,ミズクラゲを幼生から3㎝程度の大きさまで約1ヶ月で生徒たちが育てるそうです。ペットでない生き物を観察することの教育的意義は計り知れないものがあると思います。生徒の能力適性によりどんなにでも発展させることができる素晴らしい教材開発ですね。
現地研修では,はんざきセンター,蒜山塩釜養魚センター,蒜山の珪藻土採掘地,山田養蜂所,岡山県農林総合センターを巡るコースに参加しました。
はんざきセンターでは,オオサンショウウオの説明や展示の見学・餌やり体験などがありました。私が最も興味を持ったのが,オオサンショウウオの繁殖行動です。繁殖期になると,強い雄は産卵に適した洞穴に縄張りを構え,繁殖可能な雌以外はすべて追い出すそうです。ところが,いったん成熟した雌が巣の中にはいってくると追い出し行動がなくなり,結果として複数の雄が繁殖に参加できることになります。まずこの話を聞いて懐疑的な人は,「この行動は観察水槽の中で何回位確認されたのか」とか「野外でもこのような繁殖行動が確認できているのか」という点に関心を持たれるでしょう。残念ながら私もこれらの点を質問することはできていません。しかし,この観察がオオサンショウウオの繁殖行動で普通に起こることだとすれば,1個体の雌は複数の雄の遺伝子を伝えることになります。次世代には俗に言う強い雄の遺伝子だけでなく多様な遺伝子を伝えることになり,動物行動学や進化論にとって大変重要な示唆を与えてくれていると感じました。
蒜山塩釜養魚センターでは,施設の見学,釣り体験,釣った魚をその場で捌いてもらっての試食などを体験しました。失敗したのが,周辺の水路に開花していた水草の写真です。やる気を感じないのが1枚のみ。とても種の同定には使えそうにありません。一生懸命名前を思い出して,きっとバイカモだろうと思い自宅で調べてみました。そうすると,蒜山の地名がついたヒルゼンバイカモという変種があるとのことでした。本当に「初心」が大切ですね。
蒜山の珪藻土採掘地では,特別に珪藻土を採集させていただきました。土を採って喜んでいる私もかなりおめでたい存在でしょうね。
山田養蜂所は大変有名な所ですね。経営も地方創生の一助になっているようです。説明の時驚いたのは,飛んで来たキイロスズメバチに説明の方が殆ど動揺しないことです。見れば巣の入り口付近にセイヨウミツバチが塊を作っています。中にスズメバチの体が見え隠れしています。ニホンミツバチの蜂球は有名ですが,セイヨウミツバチの蜂球は2~3年前に初めて学会に報告されたそうです。セイヨウミツバチの蜂球は,ニホンミツバチの蜂球のように高温を作り出すことはできず,スズメバチの翅や足などに噛み付き自由を奪いながら仕留めていくという大変なものです。ですから,人間の保護のない野外で代を重ねるのは無理のようです。
単語は知っているが何ものかは理解していなかったのがプロポリスです。ウィキペディアには,『ミツバチが木の芽や樹液,あるいはその他の植物源から集めた樹脂製混合物である。蜂ヤニともいう。プロポリスという名前は、もともとギリシャ語で,「プロ(pro)」は「前」とか「守る(防御)」という意味を持ち「ポリス(polis)」は「都市」という意味を持っている。この2つの語が合わさったプロポリスは、「都市(巣)を守る」という意味がある。』とあります。ミツバチを飼育したときあちこちにくっついていたあの厄介なベトベトのことでした。こんなものを健康食品等にして製品化した人たちの努力を私は尊敬しますね。
最後は,岡山県農林総合センターです。バイオハザードのマークを初めてみたような気がします。研修の内容は主にバイオテクノロジーでしたが,最も印象に残ったのが遺伝子組み替えの古典的な実験,「ホタルのルシフェラーゼの遺伝子をタバコに導入する実験」でした。やったのは,極めて単純で,予め用意していただいた遺伝子組み換えと非組み換えのタバコ苗をそれぞれ一人一株ずつ暗室に持ち込みじっと待って目を慣らすだけです。何でも遺伝子は,ホタル由来
のものですが,プロモーター部分は植物由来のものを使用しているそうです。暗順応の速い人から声があがります。暫くすると,周りの株も光っているもがわかるようになります。ただ,葉が光っているだけなのですが,なぜこれがこんなに感動するのかは不思議です。私は,昔発光バクテリアでバクテリアランプを作った時の感動を思い出しました。
全体として,終活じいさんの私にとっても実り多い研修でした。できれば,若い人たちが,もっと気軽に参加できる環境ができるといいと思っています。
(H,S)
R4 日生教2021年長野大会から
日生教長野大会は,一年の延期の末,ズームでの開催へ追いこまれたようです。私のように現地研修で,ライチョウに会いにいこうなどと不純な考えのもちぬしだけではなく,何年もかけて準備してこられた関係者の方々も複雑な思いだったと思います。
残念ながら,現地研修は中止になりましたが,幸い,今回初めて全ての研究発表を聞くことができました。要旨は,ネットで閲覧もできるようです。質問は,ズームのQ&Aの機能を利用して行うので,他人の質問を遮ることはありません。今回は,信州大学の学術研究院理学系の東城幸治教授の講演,生物多様性の「世界的ホットスポット」としての信州の自然,について報告をします。
先生の研究グループでは,移動・分散の能力が高くはない河川の源流域に生息するような水生生物種群は,生物地理研究には好都合な対象であると考え,分子マーカーを用いた系統解析を実施した結果,フォッサマグナ地域が遺伝的ギャップとなる事例が多数検出されたそうです。1つの遺伝子で系統分類を語ることは,よく聞く話ですが,先生は複数の遺伝子で分析して同様な結果が得られたとのことでした。結果として,「(レジメより)フォッサマグナの西端にあたる活断層(糸魚川−静岡構造線)が縦貫する信州は,南西・東北日本の両系統の「出逢いの場」でもあります。両系統が重複分布していることでの多様性創生に加え,異なる遺伝系統同士が二次的接触することで,形質置換も生じやすくなります。このような生物多様性創生の観点において,信州は,世界的にも稀で興味深い地域の一つと言えます。生物多様性における「世界的ホットスポットのなかのホットスポット」であると言っても過言ではありません。」と主張されておられました。
この主張は私も納得ですが,途中の説明の中で気になったことがありましたので,ズームのQ&Aに質問を書き込みました。会場では取りあげてもらえませんでしたが,講演終了後に先生から回答をいただきましたので紹介します。
質問
「最後に分化した種の分布域が広いものは,どのような種ですか。」
(最後に分化した種の分布域が広くなる傾向があるという説明をうけて)
回答
トワダカワゲラ類でも2つの系統の最派生系統の分布域が広くなっております。また,トノサマガエルでも同様の系統がみられます。 植物の系統進化研究をされている方からも,派生系統の分布域が広い(=分散力が強い)ような話を聞いたことがあります。
後から派生するような系統が生き残るためには,分散力が強いようなものでないと,生き残られないようなことがあるのかもしれず,「ニワトリと卵」のようなどちらが先なのか?は難しい課題なのかもしれません。
質問の趣旨を説明すると,種分化と言えばガラパゴスのゾウガメのように,元々同一種が地理的に隔離された島で独自の進化をとげたようなイメージで捉えがちですが,地理的には隔離されていない場所で,集団の一部に遺伝的に独立した集団が産まれ,その集団が元の集団の分布を遥かに凌駕するようになった例はそんなに普通に見られるのだろうかという疑問から発せられた質問です。回答の後半部分は,私も十分には理解できていませんが,たぶん,「分散力高い集団が結果として生き残ったのか,それとも,分化が可能な集団の条件として,分散力が高くないといけないのか」とが「ニワトリと卵の関係」と説明されたのだろうと考えています。何れにせよ,「最派生系統の分布域が広くなる」ということは,普通にあることで,考えてみれば「ヒト」と呼ばれる私たちも最派生系統ですよね。
(H,S)